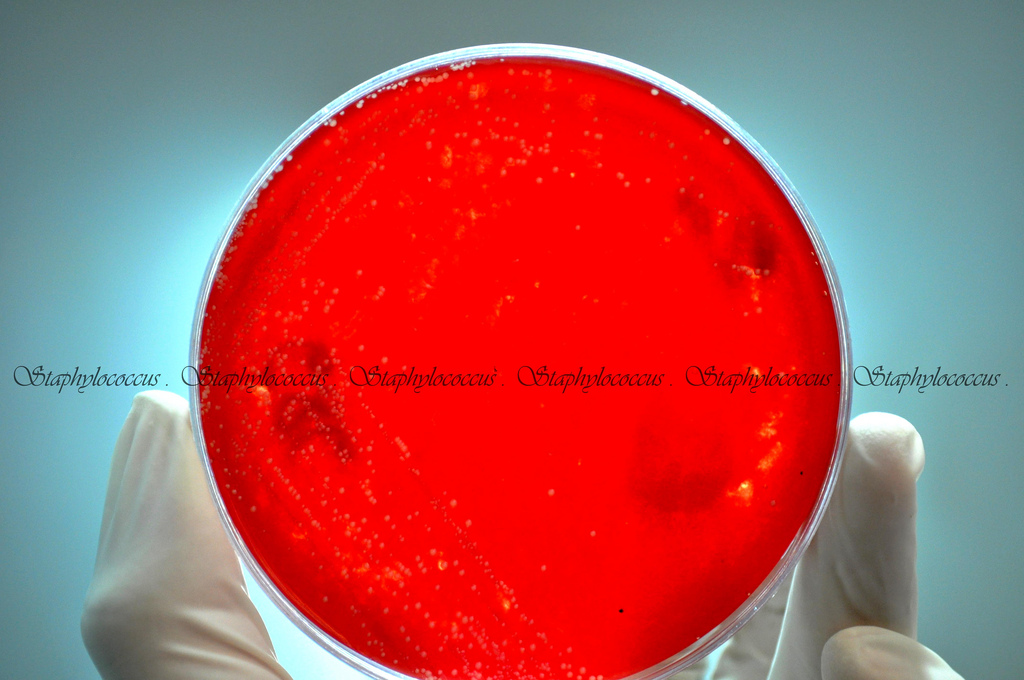

симптомы, норма, причины и лечение
Что делать, если при лабораторном исследовании обнаружили стафилококк в моче? Это, пожалуй, самый распространенный микроб, который создает трудности при лечении, так как он быстро развивает устойчивость ко многим противомикробным медикаментам. Проникает патогенный микроорганизм, которым является стафилококк, в организм двумя путями — через уретру или через кровь от инфицированных очагов. При несвоевременном лечении происходит его активное размножение и больной начинает наблюдать соответствующую симптоматику.
Разновидность болезнетворного микроорганизма
Прежде чем определить, почему в организме происходит стафилококковое поражение, необходимо ознакомиться с основными видами данного патогенного микроорганизма. Таким образом, в медицине выделяют следующие его разновидности:
- Staphylococcus epidermidis (эпидермальный стафилококк) — название микроорганизма произошло от слова «эпидермис», что означает поверхностный кожный слой.

Он приживается на всевозможных слизистых оболочках и на гладкой части кожного покрова. Эпидермальный стафилококк опасен воспалением эндокарда, заражением крови, развитием конъюнктивита и гнойного инфицирования ран. - St. saprophyticus (стафилококк сапрофитный) — считается наиболее безобидным и в основном обитает на стенках мочевого пузыря и кожных покровах возле гениталий. Сапрофитикус вызывает уретриты и циститы.
- Staphylococcus aureus (золотистый стафилококк) — является наиболее патогенным для человека и может спровоцировать воспалительные процессы практически по всему организму. St. aureus получил свое название благодаря способности проявлять золотистый пигмент.
- St. haemolyticus (гемолитический стафилококк) — данные патогенные микроорганизмы являются источником ангин, тонзиллитов и воспалений слизистой оболочки органов дыхательной системы.
Причины появления стафилококка в анализах мочи
Снижение иммунитета может стать причиной появления патогенных микроорганизмов.
Наличие в моче стафилококка может возникнуть по следующим причинам:
- Снижение защитных сил организма. Как известно, патогенные микроорганизмы присутствуют на поверхности кожи у каждого человека, но стоит иммунной системе ослабнуть, как они активизируются и «нападают» на органы.
- Заражение от инфицированных больных. При контактировании с человеком, у которого имеются открытые гнойные ранки или диагностировались ангина, пневмония, риск заражения увеличивается.
- Аллергические реакции.
- Пренебрежение личной гигиеной.
- Сахарный диабет или нарушение в работе гормональной системы.
- Употребление антибиотиков на протяжении длительного времени.
- Частые и регулярные стрессы.
- Переохлаждение, в результате которого простудились верхние дыхательные пути.
- Злоупотребление спиртосодержащими напитками, курение.
Симптомы наличия стафилококкового поражения
В зависимости от местонахождения очага с инфекцией определяется выраженность симптомов стафилококка.
Однако существует несколько общих признаков, по которым можно заподозрить в организме стафилококковое поражение. К таковым относятся:
- повышение отметок на термометре до 40-ка градусов Цельсия;
- регулярные головные боли;
- общая слабость и упадок сил.
Если больной наблюдает сильный насморк, грубый кашель и дискомфорт при мочеиспускании, то вполне вероятно, что анализ на стафилококк покажет наличие в моче его эпидермальный тип. Сбой в работе органов дыхательной системы, ухудшение аппетита, проблемы с сердцем будут свидетельствовать о стафилококке ауреус. Если пройти диагностическое обследование, то золотистый стафилококк будет обнаружен точно.
Вернуться к оглавлениюДиагностика и нормы
Общий анализ крови поможет подтвердить диагноз пациента.Чтобы подтвердить наличие в организме патогенных микроорганизмов, необходимо пройти специальную диагностику, которая включает в себя мазок из входной части женских половых органов и зева, общий анализ крови, бакпосев мочи.
На примере женщин в положении, сдавших бактериологический посев, его расшифровка выглядит таким образом:
- У беременных норма стафилококка в моче — < 1000 КОЕ/мл, что свидетельствует об отсутствии в организме очага воспаления и инфекции.
- При показателе от 1000 до 100000 КОЕ/мл — требуется повторное проведение исследования.
- Если анализ на стафилококк показал больше 100000 КОЕ/мл, то у беременной в организме имеется инфекционно-воспалительный процесс.
Правила сбора мочи
Чтобы сделать результаты максимально точными, прежде чем сдавать анализ на стафилококк, необходимо ознакомиться с основными правилами сбора исследуемого материала:
- Собирают мочу с утра сразу после пробуждения, предпочтительно на голодный желудок.
- Тщательно проводят туалет половых органов, обмывая их мыльным раствором и кипяченой водой.
- Собирают урину в специальную стерильную емкость.
- Для анализа требуется средняя порция мочи.

- Женщинам перед испусканием урины требуется прикрыть влагалище стерильным тампоном или ваткой.
Осложнения при стафилококке
Может возникнуть менингит при стафилококке.Если при лабораторном исследовании мочи был выявлен стафилококк ауреус, то следует незамедлительно начать лечение, иначе атака патогенного микроорганизма может привести к серьезным осложнениям. В таком случае больному грозит:
- сепсис;
- дерматит тяжелой формы;
- перитонит;
- поражение оболочки сердечной мышцы;
- менингит;
- тромбофлебит;
- неврологические нарушения.
Чем опасен при беременности?
Наблюдая любые изменения в организме, вплоть до появления насморка или образования прыщика, будущей маме в положении необходимо незамедлительно обратиться к специалисту, ведущему беременность, и выявить причину недуга. Если был обнаружен ауреус стафилококк при беременности, то требуется срочное лечение, которое поможет избежать тяжелых последствий как будущей матери, так и ее еще не родившемуся малышу.
При правильной и своевременной терапии можно избежать таких осложнений:
- инфицирования плода стафилококковой инфекцией в процессе родовой деятельности;
- воспаления легких, молочных желез;
- заражения плода, находящегося в утробе матери;
- стафилококковой пневмонии тяжелой формы у новорожденных;
- пороков сердца у плода;
- летального исхода будущей мамы;
- менингита новорожденных;
- гнойного поражения внутренних органов матери;
- нарушения в формировании органов внутриутробного малыша;
- выкидыша и обильного кровотечения.
Лечение стафилококкового поражения
Схему лечения прописывает врач после прохождения всех исселодований.Когда стафилококковая инфекция в моче подтвердилась специальными диагностическими обследованиями, больному назначают лечение, которое направлено на уничтожение патогенных микроорганизмов в кратчайшие сроки. Схема терапевтического курса включает в себя прием следующих видов лекарственных средств:
- антибиотики;
- бактериофаги;
- иммумодулирующие препараты;
- антибактериальные лекарства.

Профилактические мероприятия
Лечению стафилококк поддается непросто, поэтому медики рекомендуют придерживаться основных правил профилактики, которые помогут предотвратить поражение организма патогенными бактериями. Так, профилактические мероприятия включают в себя:
- сбалансированное и рациональное питание;
- соблюдение личной гигиены;
- регулярное пребывание на свежем воздухе;
- выполнение дозированной физической нагрузки;
- ежедневное проведение влажной уборки в помещение и проветривание.
Чтобы стафилококк не активизировался, необходимо избегать длительного пребывания на холоде, а также носить одежду свободного кроя и предпочтительно из натуральных тканей. Профилактика развития патогенных бактерий включает в себя специальную диагностику и терапию различных патологий острого и хронического течения. Кроме этого, важно периодически посещать женскую консультацию, а во время беременности своевременно сдавать требуемые анализы и следить за состоянием молочных желез.
стафилококк эпидермальный в моче, ответы врачей, консультация
2015-05-24 18:12:56
Спрашивает Светлана:
Здравствуйте! Волнует такой вопрос: в октябре прошлого года на подбородке стали появляться мелкие высыпания с гнойным содержимым.
Обратилась к дерматологу, сдали анализ на Демодекс-не обнаружен и посев из пустулы — обнаружили St. epidermidis 10в4 КОЕ/мл. Чувствителен к: азитромицин, эритромицин, канамицин,цефалексин, гатифлоксацин, цефиксим. Устойчив: левомицетин, цефтазидим, норфлоксацин, рифампицин.
По прошествии полторамесяца прыщи постепенно проходили, но единичные воспаления продолжали появляться. Также сама обрабатывала область спиртовым р-ром хлорофиллипта. Кожа в области поражения стала очень сухая и раздраженная, но врач по прошествии времени коррективы в лечение не вносил.
Потом я обратилась к другому специалисту. Сдала снова Демодекс — не обнаружен. Анализ мочи — никак не комментировали, все хорошо. Общий анализ и биохимию крови — слишком много показателей, не буду вдаваться в подробности, но показатели все в норме. Врач обратила только внимание, что маркер, отвечающий за поджелудочную находится на верхней границе нормы. Проблем с этой зоной у меня никогда не было, болей нет. Стул регулярный. Были назначены:Диета — исключить сладкое, кислое, соленое, острое. Атолсил 1пак 2р в день. Цетрилев 1т 1р в день. Глюконат Кальция 1т 3р в день. Элиминаль гель 1пак 3р в день. Местно: м. синтомициновая 1р в день (перед сном) и крем Атопра утром. Вся терапия 10дней. По прошествии 10 дней ушла краснота и раздражение кожи, она стала светлее, выровнялся тон, единичные белые головки появлялись редко.
Совсем перестали появляться воспаленные прыщи и подкожные, хотя их и так было 1-2. Далее прописаны:диета.Белый уголь 1т 2р в день5 дн.На 6дн по 1т 1р в день. Супрастин по 1т 2р в день. Галстена по 10 кап 3р в день. Элиминаль гель 2 пак 2 р в день. Крем Атопра утром. Тоже все 10 дн. В результате, на лице в области подбородка и крыльев носа начала появляться мелкая сыпь, которая особо ощущается при умывании подушечками пальцев и почти не заметна для окружающих. Было назначено: диета. Фенкарол 25мг по 1т 1р в день, элиминаль гель 1 пак 1 р в день 5 дн. Глюконат кальция 1т 3р в день, галстена 10кап 3р в день. Местно: утром Атопра, на ночь Бальзам стопдемодекс.Все на 10дн. В течении двух-трех дней терапии эта мелкая сыпь покрылась белыми головками, мелкими, которые немного возвышаются над поверхностью кожи(боли, зуда нет) и на данный момент на подбородке таких высыпаний порядка 15шт, возле носа до 10. Одни проходят, другие появляюся. Я перестала использование стопдемодекс, т.к. в первые дни его использования высыпаний стало значительно больше и они немного воспалились.
Сейчас использую на них 3 дня синтомициновую мазь на ночь, она снимает воспаление, новые почти не появляются. Старые начинают проходить. Понимаю, что антибиотик, долго нельзя пользоваться.
Что можете посоветовать? Подскажите, может ли это быть проявлением эпидермального стафилококка? Никаких симптомов демодекса (зуд, подкожные красные прыщи и тп) кроме этих мелких прыщей сейчас нет. Может ли это быть он или место имеет инфицирование. Нужны ли дополнительные исследования?
02 июня 2015 года
Отвечает Янченко Виталий Игоревич:
Здравствуйте! Ситуация одними антибиотиками не решается. Если решается то только в редких случаях. Очень часто могут быть рецедивы. Есть три подхода в лечении, которые я использую в клинике. Первый аутовакцина, но хорошую аутовакцину в Киеве в данное время не найдете.
В частных клиниках используют готовые штаммы, поэтому у людей много осложнений (аутоиммунные реакции на суставы и др. органы). Я использую аутогемотерапию, дезинтоксикационную и комбинирую с лечением бактериофагами.
Бесплатные консультации врачей онлайн
Вопрос создается. Пожалуйста, подождите…
Только зарегистрированные пользователи могу задавать вопрос.
Зарегистрируйтесь на портале, задавайте вопросы и получайте ответы от квалифицированных специалистов!
Напоминаем, что стоимость публикации вопроса — 10 бонусов.
Зарегистрироваться Как получить бонусы
К сожалению, у вас недостаточно бонусов для оплаты вопроса.
Напоминаем, что стоимость публикации вопроса — 10 бонусов.
Как получить бонусы
Раздел медицины*: — Не указано —КоронавирусАкушерствоАллергология, иммунологияАнестезиологияВенерологияВертебрологияВетеринарияГастроэнтерологияГематологияГепатологияГериатрияГинекологияГирудотерапияГомеопатияДерматологияДиетологияИглотерапия и РефлексотерапияИнфекционные и паразитарные болезниКардиологияКардиохирургияКосметологияЛабораторная и функциональная диагностикаЛечение травмЛогопедияМаммологияМануальная терапияМРТ, КТ диагностикаНаркологияНеврологияНейрохирургияНетрадиционные методы леченияНефрологияОбщая хирургияОнкологияОстеопатияОториноларингологияОфтальмологияПедиатрияПлазмаферезПластическая хирургияПодологияПроктологияПсихиатрияПсихологияПсихотерапияПульмонология, фтизиатрияРадиология и лучевая терапияРеабилитологияРеаниматология и интенсивная терапияРевматологияРепродукция и генетикаСексологияСомнологияСпортивная медицинаСтоматологияСурдологияТерапияТравматология и ортопедияТрансфузиологияТрихологияУЗИУльтразвуковая диагностикаУрология и андрологияФармакологияФизиотерапияФлебологияЧелюстно-лицевая хирургияЭндокринологияЗатрудняюсь выбрать (будет выбрана терапия)
Кому адресован вопросВопрос адресован: ВсемКонсультантам
Консультант, которому задается вопрос:
Всем.
..Агабекян Нонна Вачагановна (Акушер, Гинеколог)Айзикович Борис Леонидович (Иммунолог, ЛОР (Оториноларинголог), Невролог, Педиатр, Терапевт, Аллерголог, Гастроэнтеролог)Акмалов Эдуард Альбертович (Аллерголог, Врач спортивной медицины)Александров Павел Андреевич (Венеролог, Гепатолог, Инфекционист, Паразитолог, Эпидемиолог)Александрова Анна Михайловна (Педагог, Психолог, Психотерапевт)Али Мохамед Гамал Эльдин Мансур (Педиатр)Аристова Анастасия Михайловна (Андролог, Уролог, Хирург)Армашов Вадим Петрович (Хирург)Афанасьева Дарья Львовна (Кардиолог, Терапевт)Беляева Елена Александровна (Гинеколог, Невролог, Рефлексотерапевт)Бушаева Ольга Владимировна (Пульмонолог, Терапевт)Врублевская Елена (Педиатр)Гензе Ольга Владимировна (Генетик, Педиатр)Глазной Василий Иванович (Сурдолог)Горохова Юлия Игоревна (Венеролог, Врач общей практики, Дерматолог)Григорьева Алла Сергеевна (Врач общей практики, Терапевт)Демидова Елена Леонидовна (Психолог, Психотерапевт)Денищук Иван Сергеевич (Андролог, Уролог)Дибиров Магомед Гусейнович (Стоматолог)Довгаль Анастасия Юрьевна (Маммолог, Онколог, Радиолог)Долгова Юлия Владимировна (Педиатр)Дьяконова Мария Алексеевна (Гериатр, Терапевт)Жердакова Дарья Владимировна (Акушер, Гинеколог)Загумённая Анна Юрьевна (Врач спортивной медицины, Гирудотерапевт, Диетолог, Косметолог, Терапевт)Зверев Валентин Сергеевич (Ортопед, Травматолог)Згоба Марьяна Игоревна (Окулист (Офтальмолог))Зинченко Вадим Васильевич (Рентгенолог, Хирург)Зорий Евген Владимирович (Невролог, Психолог, Терапевт, Хирург)Извозчикова Нина Владиславовна (Гастроэнтеролог, Дерматолог, Иммунолог, Инфекционист, Пульмонолог)Илона Игоревна (Врач общей практики, Гастроэнтеролог, Терапевт, Эндокринолог)Калявина Светлана Николаевна (Акушер, Гинеколог)Калягина Екатерина (Другая специальность)Карпенко Алик Викторович (Ортопед, Травматолог)Касимов Анар Физули оглы (Онколог, Хирург)Киреев Сергей Александрович (Психиатр, Психолог, Психотерапевт)Кирнос Марина Станиславовна (Стоматолог, Стоматолог детский, Стоматолог-терапевт)Копежанова Гульсум (Акушер, Гинеколог)Корж Анна Анатольевна (Акушер, Гинеколог, Маммолог, Эндокринолог)Кравцов Александр Васильевич (Нарколог, Психиатр)Красильников Андрей Викторович (Врач ультразвуковой диагностики, Медицинский директор, Флеболог, Хирург)Кряжевских Инна Петровна (Терапевт, Гастроэнтеролог)Кудряшова Светлана Петровна (Эндокринолог)Куртанидзе Ираклий Малхазович (Окулист (Офтальмолог))Кущ Елена Владимировна (Диетолог, Терапевт)Лазарева Татьяна Сергеевна (ЛОР (Оториноларинголог))Лаптева Лариса Ивановна (Невролог)Лебединская Татьяна Александровна (Психолог, Психотерапевт)Ледник Максим Леонидович (Венеролог, Дерматолог)Леонова Наталья Николаевна (Детский хирург)Литвиненко Станислав Григорьевич (Ортопед, Травматолог)Лямина Ирина Алексеевна (Акушер)Максименко Татьяна Константиновна (Инфекционист)МАЛЬКОВ РОМАН ЕВГЕНЬЕВИЧ (Диетолог, Остеопат, Реабилитолог)Мамедов Рамис (ЛОР (Оториноларинголог))Мартиросян Яков Ашотович (Детский хирург, Проктолог, Травматолог, Уролог, Хирург)Маряшина Юлия Александровна (Акушер, Венеролог, Врач ультразвуковой диагностики, Гинеколог, Педиатр)Матвеева Ярослава Дмитриевна (Педиатр)Мельшина Алёна Игоревна (Окулист (Офтальмолог))Мершед Хасан Имадович (Вертебролог, Нейрохирург)Миллер Ирина Васильевна (Невролог)Мильдзихова АЛЬБИНА Бексолтановна (Врач общей практики, Гинеколог, ЛОР (Оториноларинголог), Педиатр, Терапевт)Муратова Наталья Сергеевна (Врач общей практики, Диетолог)Мухорин Виктор Павлович (Нефролог)Наумов Алексей Алексеевич (Мануальный терапевт)Никитина Анна Алексеевна (Окулист (Офтальмолог))Никишин Андрей Александрович (Психиатр, Психолог, Психотерапевт)Ольга Викторовна (Невролог, Неонатолог, Педиатр, Реабилитолог, Терапевт)Павлова Мария Игоревна (Стоматолог, Стоматолог-хирург, Челюстно-лицевой хирург)Панигрибко Сергей Леонидович (Венеролог, Дерматолог, Косметолог, Массажист, Миколог)Пантелеева Кристина Алексеевна (Невролог)Пастель Владимир Борисович (Ортопед, Ревматолог, Травматолог, Хирург)Паунок Анатолий Анатольевич (Андролог, Уролог)Першина Наталия Сергеевна (Невролог)Пикульская Вита Григорьевна (Терапевт)Прокофьева Анастасия Михайловна (ЛОР (Оториноларинголог))Прохоров Иван Алексеевич (Нейрохирург, Хирург)Пушкарев Александр Вольдемарович (Гинеколог, Психотерапевт, Реабилитолог, Репродуктолог (ЭКО), Эндокринолог)Пьянцева Екатерина Вячеславна (Педиатр)Радевич Игорь Тадеушевич (Андролог, Венеролог, Сексолог, Уролог)Сапрыкина Ольга Александровна (Невролог)Свечникова Анастасия Евгеньевна (Стоматолог, Стоматолог детский, Стоматолог-ортопед, Стоматолог-терапевт, Стоматолог-хирург)Семений Александр Тимофеевич (Врач общей практики, Реабилитолог, Терапевт)Сергейчик Никита Сергеевич (Анестезиолог, Гомеопат)Силуянова Валерия Викторовна (Акушер, Врач ультразвуковой диагностики, Гинеколог)Соболь Андрей Аркадьевич (Кардиолог, Нарколог, Невролог, Психиатр, Психотерапевт)Солдатов Вадим Александрович (Невролог)Сошникова Наталия Владимировна (Эндокринолог)Степанова Татьяна Владимировна (ЛОР (Оториноларинголог))Степашкина Анастасия Сергеевна (Гематолог, Пульмонолог, Терапевт)Сурова Лидия (Гирудотерапевт, Невролог, Терапевт)Суханова Оксана Александровна (Клинический фармаколог, Психолог)Сухих Данил Витальевич (Психиатр)Тимченко Алла Владимировна (Дерматолог, Косметолог)Тихомиров Сергей Евгеньевич (Нейрохирург)Тумарец Кирилл Михайлович (Врач лечебной физкультуры, Врач спортивной медицины, Кинезитерапевт, Реабилитолог, Физиотерапевт)Турлыбекова Венера Равильевна (Врач общей практики, Педиатр)Устимова Вера Николаевна (Гематолог, Терапевт, Трансфузиолог)Фатеева Анастасия Александровна (Гастроэнтеролог, Диетолог, Психотерапевт, Эндокринолог)Федотова Татьяна Владимировна (Врач ультразвуковой диагностики, Гематолог, Терапевт)Фомина Ольга Владимировна (Гематолог, Маммолог, Нарколог, Онколог)Фоминов Олег Эдуардович (Сексолог)Фоминов Олег Эдуардович (Сексолог)Фурманова Елена Александровна (Аллерголог, Иммунолог, Инфекционист, Педиатр)Хасанов Эльзар Халитович (Андролог, Врач ультразвуковой диагностики, Онколог, Уролог, Хирург)Хасанова Гульнара Сунагатулловна (Акушер, Врач ультразвуковой диагностики)Чупанова Аида (Акушер, Гинеколог)Чупанова Аида Идаятовна (Акушер, Гинеколог, Репродуктолог (ЭКО))Швайликова Инна Евненьевна (Окулист (Офтальмолог))Шибанова Мария Александровна (Нефролог, Терапевт)Щепетова Ольга Александровна (Терапевт)Ягудин Денар Лукманович (ЛОР (Оториноларинголог))Ярвела Марианна Юрьевна (Психолог)
Описание проблемы:
Пол: —укажите пол—ЖенщинаМужчина
Возраст:
Категория 18+: Обычный18+
Стафилококкозы собак — Ветеринария и жизнь
Большое количество возбудителей в окружающей среде значительно усложняют жизнь домашних животных, в частности собаководов.
Оградить животное от всех патогенов невозможно.
Поэтому, необходимо знать, как проявляются признаки заражения теми или иными микроорганизмами, в частности, патогенными стафилококками, и как лечить отдельно взятую инфекцию. Особенно распространены среди собак стафилококкозы.
Стафилококкозы — это группа заболеваний, причиной которых являются патогенные стафилококки видов: Staphylococcus aureus, Staphylococcus haemolyticus, Staphylococcus intermedius, Staphylococcus pseudintermedius, Staphylococcus epidermidis. Патология может развиваться по двум основным путям. Первый заключается в том, что стафилококк самостоятельно вызывает заболевание. В том случае, если он присоединяется к уже существующей проблеме, речь ведут о вторичной форме. Таким образом, стафилококк у собак может поражать различные органы (кожу, глаза, уши, слизистые оболочки носовой и ротовой полостей, мочеполовую систему, кровь и др.), но благодаря тому, что имеются характерные симптомы, можно вовремя заметить заболевание и начать лечение.
Стафилококк относится к грамположительным микроорганизмам. Он имеет шаровидную форму и определяется в виде скоплений, напоминающих гроздь винограда. Название бактерий возникло от лат. Staphylococcus, от греч. σταφυλή — «гроздь винограда» и греч. κόκκος — «зерно, ягода».
У каждой собаки имеется своя предрасположенность к возбудителю или же напротив, устойчивость.
При высокой сопротивляемости организма для инфицирования необходима огромная доза заражения.
В то же время, следует выделить основные предрасполагающие факторы, способствующие заболеванию:
— высокий уровень углеводов в организме собак;
— нарушение иммунитета;
— авитаминозы, а точнее недостаток витаминов A, E, группы В;
— отравление организма;
— заболевания кожи, в частности, клещи,блохи, аллергические реакции и пр.;
— настроенность иммунной системы в виде отсутствия устойчивости именно к этому возбудителю.
Практически все симптомы, которые вызывает стафилококк, связаны с состоянием кожи. Возможно, это объясняется тем, что у животного кожа не способна выполнять защитную функцию также эффективно, как, например, кожа человека. Наиболее часто регистрируется пиодермия, вызвать которую могут: золотистый стафилококк, гемолитический, псевдоинтермедиус и интермедиус, иногда эпидермальный стафилококк. Данная патология классифицируется в зависимости от того, на какую глубину распространяется патологический процесс. Поверхностная форма выражается в виде появления неглубоких эрозий и не сильно выраженного зуда. Прикосновение к ним вызывает болевые ощущения. Данная форма может быть с появлением влажных эрозий. Их провоцирует травма кожи или постоянное расчесывание вследствие наличия паразитов на коже собаки. Наиболее часто при этом золотистый стафилококк выявляется в области хвоста, на шее, под грудью и на лапах, в тех местах, где кожа наиболее тонкая и, следовательно, более уязвимая.
Обострение заболевания может быть летом или весной, то есть в теплое время года.
Кроме этого пиодермия с поверхностным поражением кожи может регистрироваться у собак с выраженными кожными складками. В процессе жизнедеятельности в них скапливаются различные выделения и остатки корма. При отсутствии проветривания присоединяется инфекция, которой, как правило, и являются патогенные виды стафилококков.
Помимо кожного покрова, у собак стафилококк может поражать и слизистые оболочки ротовой полости, глаз, репродуктивных органов; уши.
Есть еще один симптом, который часто регистрируется у собак и не всегда владельцы догадываются, что его причиной также является стафилококк. Речь идет об отитах. Это может быть скрытое течение или бурно протекающая болезнь. В некоторых случаях патология поражает даже ткани внутреннего уха, что проявляется в виде язв и эрозий. Если данную патологию вовремя не вылечить, то может присоединиться конъюнктивит и ринит.
Чтобы распознать у собаки стафилококкоз, необходимо как можно раньше обратиться к врачу при появлении первых симптомов.
Основой диагностики стафилококкоза является бактериологический анализ. В качестве патологического материала в лабораторию направляют: пробы гноя, мокроты, смывы из носа, рта, дёсен, ушей и конъюнктивы, кровь, испражнения, пунктат из уха, соскобы с кожи, материалом для бактериологического исследования могут также служить пробы корма.
Специалисты ФГБУ «Краснодарская МВЛ» проводят диагностику стафилококкозов собак при помощи классических бактериологических методов, а также импортных тест-систем. Срок исследования составляет 4-5 дней.
Своевременно поставленный диагноз позволит грамотно провести лечение с учётом чувствительности выделенной культуры стафилококка к антибактериальным препаратам, получить лечебный эффект.
Источник: пресс-служба ФГБУ «Краснодарская МВЛ»
Подпишитесь на нас в ЯНДЕКС.
НОВОСТИ и в Telegram , чтобы читать новости сразу, как только они появляются на сайте.
staphylococcus epidermidis, норма и лечение, стрептококк в моче, в посеве у мужчин
Стафилококк эпидермис относится к условно-патогенным бактериям, которые инфицируют ткани организма человекДовольно часто стафилококк эпидермис проявляет свою деятельность в поверхностном слое кожи. Микроорганизмы долгое время могут себя никак не выдавать, так как обладают низким инфекционным потенциалом. Эпидермальный стафилококк практически никогда не приводит к серьезным заболеваниям. К основным причинам поражения эпидермидиса относят неправильную гигиену и инфицирование от носителя бактерий.
Staphylococcus epidermidis: норма и симптомы
Эпидермальные инфекции развиваются из-за высокой устойчивости бактерий к неблагоприятным условиям. Бактерии быстро размножаются, но при этом их сложно обнаружить, поэтому зачастую они присутствуют даже в медицинских учреждениях. Пациенты могут инфицироваться во время терапевтической и диагностической манипуляции: заборе крови, операции и т.д.
После попадания в верхний слой кожи бактерия начинает свое активное размножение и проникает непосредственно в кровь.
Ток крови разносит бактерии по различным органам, тем самым формирует хронические воспалительные очаги. Привести к инфицированию стафилококком может дисфункция иммунной системы. Если иммунитет недостаточно силен, он не может подавить стафилококк, что приводит к его активизации и распространению по всему организму.
Эпидермальные инфекции развиваются из-за высокой устойчивости бактерий к неблагоприятным условиям
Симптомы стафилококка:
- На дерме появляются фурункулы, карбункулы, угревая сыпь.
- Бактерия может размножаться на продуктах, что приводит к отравлениям.
- Пожилые люди и дети страдают от поражения стафилококком толстого кишечника, что приводит к острому колиту.
Протекание стафилококка почти бессимптомно, поэтому возможно формирование очагов вторичного воспаления. К клиническим симптомам можно отнести общую интоксикацию, повышение температуры тела, общую слабость и недомогание, головную боль. К прочим симптомам может добавиться дисфункциональное поражение определенных органов.
Какие заболевания вызывает стрептококк эпидермис
Многие патогенные организмы потенциально опасны для здоровья человека. К самой обширной группе относятся бактерии, окружающие нас везде. Бактерии могут иметь разную форму. Они бывают шарообразными, спиралевидными, в форме палочки и т.д.
Стрептококки выглядят как цепочки, имеющие шарообразную или яйцеподобную форму.
Стрептококки относят к анаэробным паразитам, которые зачастую размножаются в органах дыхания, ЖКТ, мочеполовой системе и на коже. Самое большое количество бактерий располагается в носу, во рту, в горле и кишечнике. Иногда бактерии могут поразить уретру у мужчин или влагалище у женщин.
Стрептококки выглядят как цепочки, имеющие шарообразную или яйцеподобную форму
Какие заболевания вызывает стрептококк:
- Бронхит;
- Гломерулонефрит;
- Васкулит;
- Импетиго;
- Менингит;
- Острый тонзиллит;
- Пневмония;
- Сепсис;
- Ревматизм;
- Стрептодермия.
Стрептококковая инфекция часто присоединяется к стафилококкам, энтерококкам и другим бактериям. Чаще всего стрептококки приводят к болезни детей и людей пожилого возраста. К заболеванию приводит два фактора: контакт с данным видом бактерии и ослабленная иммунная система.
Стафилококк эпидермис: лечение травами
Эпидермальный стафилококк относят к болезнетворным бактериям, которые приживаются на всех слизистых облачках, а также на гладких участках кожи. Данный вид стафилококка представляет нормальную микрофлору человеческой кожи, поэтому при сильном иммунитете бактерии не наносят здоровью никакого вреда. Обычно стафилококки приводят к болезням людей с ослабленным и истощенным организмом.
Бактерии могут проникнуть внутрь организма при наличии у человека ран, через сосудистые и мочевые катетеры или дренажи.
Если эпидермальным стафилококком инфицировалась женщина, скорее всего, она будет страдать от воспаления мочеиспускательного канала. Для того чтобы начать лечить заболевание, необходимо провести полную диагностику организма, чтобы назначить эффективные вспомогательные медикаменты. Лучший способ избежать заражения – следовать правилам личной гигиены.
Лечение травами обходится относительно недорого, но при этом отличается большой эффективностью
Почему эффективно лечение травами:
- Оказывают губительное воздействие на вирусы, микробы и грибы.
- Повышают иммунитет.
- Способствуют уменьшению воспалительного процесса и снижению температуры.
Правильное применение трав обычно безопасно. Лечение травами обходиться относительно недорого, но при этом отличается большой эффективностью. Отлично борются с эпидеминальным стафилококком эвкалипт, череда, подорожник, барбарис, душица, смородина, земляника.
Причины появления Staphylococcus epidermis в моче
Эпидермальный стафилококк является распространенным видом микробов, которые лечатся довольно сложно, так как отличается большой устойчивостью к различным медикаментозным препаратам. Проникнуть в организм он может несколькими способами: через уретру или раны в теле.
Эпидермальный стафилококк отлично приживается на слизистых оболочках и кожном покрове (его гладкой части).
Опасность эпидермального стафилококка заключается в возможности начала воспалительного процесса в эндокарде. Размножение стафилококка может также привести к заражению крови, развитию конъюнктивита и гнойному инфицированию ран. В моче патогенным микроорганизмы появляются из-за ослабления иммунной защиты организма.
В моче патогенные микроорганизмы появляются из-за ослабления иммунной защиты организма
Причины появления бактерий в моче:
- Заражение стафилококком от инфицированного больного;
- Аллергия;
- Несоблюдение правил личной гигиены;
- Регулярные стрессы;
- Переохлаждение;
- Злоупотребление спиртным и курением.
Симптоматика наличия стафилококков можнт быть разной. На это влияет локализация инфекционного очага. Стафилококковое поражение можно распознать по сильно высокой температуре, регулярным головным болям, общей слабости и упадку сил.
Чем опасен стафилококк эпидермис (видео)
Эпидермальный стафилококк – разновидность бактерий, которая отлично приживается на слизистых оболочках и гладком кожном покрове. Эпидермальный стафилококк может поразить мочеполовую систему, ЖКТ, а также проявиться в глазах. Если при посеве выявили стафилококк, врач назначает проведение дополнительного обследования, которое поможет поставить точный диагноз и назначить эффективное лечение.
Добавить комментарий
Для чего нужно проверять кровь на стерильность?
В ТОГБУЗ «ГКБ им. Арх. Луки г. Тамбова» прошло очередное занятие в «Школе практического мастерства». Вели занятие, посвященное вопросам посева крови на стерильность и посева мочи для ее количественного экспресс-исследования, старший лаборант бактериологической лаборатории О. В. Бирюкова и Е. Н. Герасименко.
Для чего нужно проверять кровь на стерильность? Ответ на этот простой, казалось бы, вопроси обусловливает важность темы данного занятия не только для специалистов бактериологической службы больницы, но и для всего ее среднего медперсонала. А в преддверии сезонных респираторных заболеваний она особенно актуальна.
Дело в том, что в современной диагностической практике анализ крови на стерильность проводят для того, чтобы узнать о наличии бактериемии. Сдавать кровь на стерильность врачи рекомендуют непосредственно перед процессом терапии, остерегаясь получить неправильный результат.Показанием к проведению такого анализа может служить определение в крови патогенных микроорганизмов.
Примерами последних могут быть стрептококки, синегнойные палочки, золотистые стафилококки, дрожжевые грибы и энтеробактерии. Например, для обнаружения заражения эпидермальным стафилококком необходимо провести многократное тестирование.
Такие виды исследований очень важны для больных людей с низким иммунитетом. К примеру, зараженные ВИЧ-инфекцией пациенты могут быть обладателями микобактерий туберкулеза.
В большинстве случаях анализ делают в тех случаях, когда у пациента уже длительное время держится и не спадает высокая температура, причем происходит это без особых на то причин. Помимо всего, анализ назначают при подозрении на сепсис или менингит.
Проведение этого анализа помогает определить бактерии, содержащиеся в составе крови. Это могут быть как опасные, так и условно-патогенные бактерии, которые также могут оказаться причиной болезни. Помимо того, что проведением анализа можно установить наличие определенной бактерии, можно определить и стадию, на которой находится заболевание.
Если посев крови проводится с целью определения чувствительности организма к разнообразию антибиотиков, то анализ поможет установить тип возбудителя и назначить подходящие антибиотики для проведения лечения. В данном случае анализ поможет определить неэффективное использование предыдущих антибиотических препаратов; наличие менингита или сепсиса, а также гнойничковое поражение кожи.
Перед проведением анализа необходимо придерживаться самых стандартных правил – пару дней не пить алкоголь, не употреблять жирную пищу, постараться отказаться от курения, хотя бы за пару часов до проведения анализа. Прием лекарственных препаратов назначается после проведения анализа.
Во время проведения анализа отдельное внимание стоит обратить на тот факт, что в 3% случаях эпидермальный стафилококк (загрязненная микрофлора кожи) может выступить в качестве гемокультуры. Именно поэтому его клиническое значение определяется только после многократных исследований.
Во время исследования необходимо произвести забор крови из вены у локтевого сгиба. У детей младшего возраста забор крови производится из пальца, пятки, мочки уха в меньшем количестве. Кровь для проведения анализа берут только после тщательной обработки кожи, соблюдая все правила асептики, используя одноразовый стерильный шприц.
Посев на питательные среды стерильного материала (кровь или другие, содержащие микробов жидкости у здоровых лиц) также лучше делать у постели больного, либо помещать в стерильную посуду, содержащую вещества, препятствующие свертыванию крови 0,3% раствора цитрата натрия, 0,1% раствор оксалата натрия). Обычно берут 5-10мл крови и засевают во флакон, содержащий 50-100 мл среды. Для этого используют для флакона с питательной средой (один для аэробов, другой для анаэробов). Посев крови производится на жидкие питательные среды – 10% желчный бульон, 1% сахарный бульон, двухфазную среду, а также жидкие и полужидкие среды для культивирования анаэробов в разведении 1:10. Флаконы с питательной средой получают в лаборатории, переливание крови из шприца во флакон необходимо производить над пламенем спиртовки, предварительно сняв иглу. Флакон с посевом направляется в лабораторию, а в вечернее и ночное время помещают в термостат.
Важным моментом является тот факт, что чем раньше произвести посев от начала болезни, тем больше возможность получить положительный результат, и наоборот, чем позднее, тем меньше шансов. При нормальной температуре получения положительного результата бывает очень редко.
Техника посева позволяет увидеть, как растут колонии, а также провести с образцовыми цепочками микроорганизмов тесты, позволяющие окончательно определить их тип.
Кровь для бактериологического посева необходимо сдавать до начала лечения антибиотиками, поскольку употребление антибиотиков может отсрочить или предотвратить рост бактерий, что приведет к ложноотрицательному результату. У пациентов с периодическим повышением температуры тела кровь нужно брать в период, когда температура растет или сразу же после прохождения пика температуры. Именно в это время в крови находится максимальное количество бактерий. Во многих лабораториях специалисты рекомендуют сдать второй образец крови не позднее, чем через один час после первого, для того, чтобы увеличить шансы обнаружения бактерий.
При бактериологическом посеве нужно придерживаться асептической техники, чтобы исключить возможность бактериального загрязнения крови. Если образец взят согласно правилам, в бутылку с питательной средой попадут только те микроорганизмы, которые находится в крови больного.
Правила взятия крови для бактериологического посева:
Кровь следует брать из периферической вены, без использования катетера, чтобы исключить загрязнение.
Процедура выполняется в стерильных перчатках. Место венепункции смазывается антисептиком.
Также антисептиком дезинфицируется и крышка бутылки с питательной средой.
Кровь берется стерильным шприцем.
В бутылку кровь вносится через резиновую пробку. Снимать пробку с бутылки нельзя.
Культура крови снабжается этикеткой с данными о пациенте.
Результаты бактериологического посева крови делятся на следующие три группы:
– роста бактерий нет;
– чистый рост бактерий;
– смешанный рост бактерий.
Отсутствие роста бактерий: нормальный результат, означающий, что кровь пациента стерильна.
Чистый рост бактерий: результат, означающий, что имеется рост одного вида бактерий, который был выделен из культуры. Получения такого результата следует ожидать, когда у пациента сепсис.
Смешанный рост: результат указывает на то, что из культуры было выделено более одного вида бактерий. Такое инфицирование крови случается редко. Чаще всего, смешанный рост бактерий является подтверждением того, что питательная среда была загрязнена.
Слушателям школы практического мастерства был продемонстрирован и дипстрик – полуавтоматическое устройство, правильно пользоваться которым может даже неквалифицированный медицинский персонал или пациенты в амбулаториях, стационарах и даже домашних условиях. Применение Дипстрика позволяет повысить безопасность бактериологического анализа мочи, так как в лабораторию вместо них поступают посевы в закрытых контейнерах.
Анализ на стафилококк ᐈ бакпосев на стафилококк
Описание анализа:
Бакпосев на стафилококк – анализ, позволяющий определить, инфицирован ли человек золотистым стафилококком – самой распространенной причиной стафилококковых инфекций.
Эти бактерии встречаются у каждого третьего здорового человека, располагаясь на коже, слизистых носа, гортани, кишечника или влагалища, и не приносят организму вреда. Но в случае ослабления иммунной системы, повреждения слизистой или изменения состава микрофлоры, золотистый стафилококк начинает активно размножаться, провоцируя появление разнообразных заболеваний.
Если бактерия поражает органы дыхательной системы, то возможно развитие воспаления легких, синуситов, ларингита, трахеита, ангины или отита. Если золотистый стафилококк начинает активно размножаться на коже, то появляются симптомы импетиго, фолликулита, возможно появление карбункулов. Поражение молочной железы может привести к маститу.
Бактерия способна вырабатывать энтеротоксин, потому заселение ею желудочно-кишечного тракта влечет симптомы энтероколита, возможно появление холецистит. В сложных случаях из-за золотистого стафилококка развивается аппендицит, перитонит или парапроктит.
При заселении золотистым стафилококком мочевыводящих путей может развиться пиелонефрит, цистит или уретрит. Бактерия способна поражать даже кости и суставы, вызывая остеомиелит и артрит.
В самых сложных случаях инфекция генерализируется – распространяется на весь организм, провоцируя развитие сепсиса и токсический шок.
Заражение может проходить воздушно-пылевым или контактным путем, основными источниками стафилококковой инфекции являются больные люди, здоровые носители, домашние животные и зараженная еда.
Группу повышенного риска инфицирования составляют пациенты со слабым иммунитетом, сахарным диабетом, онкологическими патологиями, ранами и травмами или находящиеся на гемодиализе. Также уязвимы перед инфекцией люди преклонного возраста, дети и женщины в период лактации. Отдельная группа риска – персонал лечебных заведений, так как золотистый стафилококк является самой распространенной причиной внутрибольничных инфекций.
При отборе мазка на бакпосев у зараженного человека, в течение суток в питательной среде развиваются колонии бактерий золотистого цвета, которые и дали название возбудителю болезни.
Показания к назначению анализа на стафилококк
Исследование может быть назначено широким кругом специалистов, но чаще всего назначение выписывают терапевты, педиатры, инфекционисты и отоларингологи (ЛОР).
Показанием для назначения может являться:
- подозрение на стафилококковую инфекцию или бессимптомное носительство;
- дифференциальная диагностика фарингитов, ангин, ОРВИ и пр.;
- контроль эффективности лечения;
- внутрибольничная инфекция в медицинском учреждении;
- беременность;
- профилактика золотистого стафилококка (для медработников, иногда для пациентов перед госпитализацией).
Подготовка к исследованию
Забор материала важно проводить до начала прием антибиотиков. Если на анализ сдается мокрота, то за 8-12 часов до сдачи образца рекомендовано пить большое количество воды. При сдаче образца мочи нельзя употреблять мочегонные препараты, при сдаче образца кала – слабительное, свечи, масла и препараты, способные окрасить кал или сказаться на перистальтике.
Если сдается урогенитальный мазок или моча, то мужчинам нужно не мочиться несколько часов перед исследованием, а женщинам желательно сдавать образец до наступления месячных или спустя несколько дней, после их окончания.
Материал для анализа: урогенитальный мазок, моча, кал, мазок из носа или ротоглотки, грудное молоко.
Срок проведения: 5 рабочих дней.
Запись на анализы
Staphylococcus epidermidis в моче не всегда является доброкачественным: отчет о пиелонефрите у ребенка
Abstract
Цель: Staphylococcus epidermidis в посевах мочи от ранее здоровых детей обычно считается контаминантом. Целью этого исследования было выявить случаи, в которых S. epidermidis был инфекционной причиной инфекции мочевыводящих путей (ИМП) у детей.
Методы: Поиск в литературе выявил 7 случаев, 6 из которых были ранее опубликованы, а 1 неопубликованный, описанных здесь.
Результаты: S. epidermidis был идентифицирован как возбудитель ИМП у детей с основными патологиями мочевыводящих путей.
Заключение: ИМП, вызванных S. epidermidis у ранее здорового ребенка, не следует игнорировать как контаминант, и показано дальнейшее обследование по поводу патологии мочевыводящих путей.
У здоровых детей инфекции мочевыводящих путей (ИМП) обычно вызываются грамотрицательными организмами (в основном, Escherichia coli) и некоторыми грамположительными организмами, такими как Staphylococcus saprophyticus и Enterococcus. 1 Когда Staphylococcus epidermidis выделяется в посеве мочи, предполагается, что он является контаминантом. 2 Однако, как показано в следующем случае, это предположение не следует делать в отношении ребенка с симптомами, у которого не может быть идентифицирован альтернативный источник инфекции. Этот случай также подчеркивает важность подозрения на лежащую в основе аномалию мочевыводящих путей, когда S. epidermidis идентифицируется как возбудитель ИМП у детей.
История болезни
У ранее здорового 4-летнего обрезанного мальчика в течение 1 дня наблюдалась лихорадка, боли в животе и рвота.Общий анализ мочи показал от 4 до 6 лейкоцитов на поле высокой мощности и умеренное количество бактерий. Его симптомы продолжали ухудшаться; его количество лейкоцитов было 23 900 / мм 3 (83,7% нейтрофилов, 9,2% лимфоцитов, 6,5% моноцитов), а его концентрация C-реактивного белка составляла 5,8 мг / дл. Он был госпитализирован по поводу обезвоживания и синдрома системной воспалительной реакции. Визуализация была сделана, чтобы исключить аппендицит и пневмонию.
На 3-й день госпитализации уровень С-реактивного белка повысился до 20 мг / дл, и посев мочи вырос на> 100000 колониеобразующих единиц (КОЕ) S.epidermidis / мл. Из-за нежелания приписывать болезнь пациента S. epidermidis, посев мочи был повторен и снова вырастил 100 000 КОЕ S. epidermidis / мл. Пациенту вводили левофлоксацин 10 мг / кг внутривенно два раза в день, и в течение 12 часов его состояние вернулось к исходному уровню.
Новый рабочий диагноз — вторичный сепсис по отношению к пиелонефриту, после чего было назначено ультразвуковое исследование почек, которое показало нормальные почки с обеих сторон; мочевой пузырь был расширен не полностью, но в целом нормальный.
Пациент завершил 3-дневный курс внутривенного введения левофлоксацина и был отправлен домой с пероральным левофлоксацином на 12 дней. Амбулаторная везикоцистоуретограмма выявила рефлюкс II степени справа и отсутствие рефлюкса слева. Пациентка направлена в урологию для наблюдения.
Обсуждение
S. epidermidis обычно не считается возбудителем ИМП у детей без ранее существовавших заболеваний. Этот микроорганизм чаще ассоциируется с ИМП у пациентов с постоянными мочевыми катетерами и другими инструментами в мочевыводящих путях. 3 При выращивании в культуре у здорового пациента S. epidermidis традиционно считался контаминантом. Этот случай и 6 других подобных ему (суммированных в таблице 1) доказывают, что этого предположения следует избегать у пациентов с симптомами.
Таблица 1. Отчеты о случаях ранее здоровых мальчиков, у которых была инфекция мочевыводящих путей, вызванная Staphylococcus epidermidis , и аномалия мочевыводящих путей, обнаруженная в каждом случаеПоиск литературы в PubMed проводился с использованием следующих терминов: Staphylococcus epidermidis, инфекция мочевыводящих путей , здоровых и пиелонефритов и отфильтрованных до возраста от 0 до 18 лет.Было выявлено четыре случая ИМП, вызванных S. epidermidis, которые подробно описаны в таблице 1. Все выявленные случаи произошли у ранее здоровых мальчиков, большинство из которых были обрезаны. Большинство пациентов предъявляли жалобы со стороны желудочно-кишечного тракта и им был неправильно поставлен диагноз вирусного гастроэнтерита после исключения аппендицита. Хотя не у всех пациентов наблюдалась явная пиурия в анализе мочи, во всех случаях посев мочи увеличивался более чем на 100 000 КОЕ / мл. Все пациенты лечились антибиотиками и полностью выздоровели в течение нескольких дней.Наибольшее значение имеет то, что у всех детей были выявлены основные аномалии мочевыводящих путей, подробно описанные в таблице 1, которые были выявлены с помощью УЗИ почек и пузырно-цистоуретограммы.
Заключение
Хотя S. epidermidis классически считался загрязнителем мочи, следует соблюдать осторожность, прежде чем делать это предположение. У пациента с симптомами и повторным положительным посевом мочи возможность ИМП, вызванного S. epidermidis, должна рассматриваться как причина симптомов пациента.Помимо лечения соответствующими антибиотиками, необходимо дальнейшее обследование основных патологий мочевыводящих путей.
- Получено для публикации 10 апреля 2014 г.
- Исправление получено 21 июля 2014 г.
- Принято к публикации 29 июля 2014 г.
Пиелонефрит, устойчивый к метициллину, Staphylococcus epidermidis, приобретенный у ребенка: отчет о клиническом случае | Журнал медицинских историй болезни
S. epidermidis обязан своим патогенетическим успехом двум основным характеристикам: его естественной нише на коже человека, что обеспечивает легкий доступ к любому устройству, вставленному или имплантированному через кожу, и его способности прикрепляться к биоматериалам и формировать биопленку [10, 11].Организмы прикрепляются к протезному материалу, а затем образуют многослойные кластеры, которые внедряются в матрицу экзополисахарида, образуя таким образом биопленку. Биопленка защищает организмы от фагоцитарных клеток и снижает проникновение антибиотиков, и, таким образом, по-видимому, облегчает инфекцию, защищая эти обычно низковирулентные организмы от уничтожения защитой хозяина или антимикробной терапией [3, 10, 11].
Лечение инфекций, вызванных S. epidermidis , как правило, затруднено из-за повышения устойчивости ко многим антибиотикам.В частности, количество штаммов, проявляющих устойчивость к метициллину, антибиотику первого выбора против стафилококков, быстро растет в течение многих лет [12]. Приблизительно от 75 до 90% госпитальных изолятов S. epidermidis проявляют устойчивость к метициллину во всем мире [13]. Помимо устойчивости к метициллину, большинство изолятов S. epidermidis устойчивы к другим антибиотикам; большинство штаммов оказались устойчивыми к фторхинолонам и макролидам, а многие штаммы были устойчивы к клиндамицину и TMP / SMX в Северной Америке и Великобритании [10].Хотя это в основном связано с высокими показателями устойчивости к антибиотикам среди нозокомиальных изолятов S. epidermidis , неэффективность лечения также связана со способностью S. epidermidis образовывать биопленки на инертных поверхностях медицинских устройств, что увеличивает сложность удаления эти липкие многослойные скопления бактерий [14].
При ИМП у детей S. epidermidis выделяется редко; действительно, в обзоре английской литературы мы нашли только шесть зарегистрированных случаев (Таблица 2) [6–9].В отличие от нашего случая, во всех шести зарегистрированных случаях впервые развился пиелонефрит, вызванный S. epidermidis , и ранее не применялись антибиотики. Ни в одном из случаев, включая наш случай, не использовался мочевой катетер, и все они были иммунокомпетентными. Кроме того, все пациенты, кроме одного, были подростками. Примечательно, что во всех случаях были нарушения мочеиспускания; у четырех был тяжелый ПМР (степень III и выше), и хотя у двух других не было рефлюкса, у них действительно был дивертикул мочевого пузыря, который может привести к застою мочи.Эти предыдущие отчеты и подробности нашего случая демонстрируют, что ИМП, вызванная S. epidermidis , может возникать у людей любого возраста, даже у иммунокомпетентных детей, и все восприимчивые пациенты имеют очевидные лежащие в основе аномалии мочевыводящих путей. Несмотря на то, что подробное описание модели восприимчивости не было предоставлено, а метициллин-резистентный S. epidermidis не был указан в предыдущих отчетах, в таких случаях считаются необходимыми антибиотики, отличные от пенициллинов и цефалоспоринов.
Таблица 2 Обзор литературы о педиатрических случаях инфекций мочевыводящих путей, вызванных Эпидермальный стафилококкПатогенез S. epidermidis ИМП в ранее описанных случаях и в нашем случае остается неясным. Многочисленные исследования ясно показали, что способность образовывать биопленки на инертных поверхностях является типичной чертой внутрибольничных инфекций.Бактерии прикрепляются к поверхности за счет неспецифических факторов, таких как гидрофобность и поверхностный заряд, а за начальной стадией прилипания следует накопление биопленки [11, 12]. Как упоминалось выше, в нашем случае при обращении не было мочевого катетера и никаких признаков иммунологической проблемы. Следовательно, согласно предыдущим сообщениям, тяжелая ПМР, связанная с расширенными мочеточниками, может каким-то образом быть предрасполагающим фактором риска для инфекции S. epidermidis . Более того, примечательно, что в нашем случае S.epidermidis был чувствителен к TMP / SMX, хотя наш пациент ранее получал CAP с профилактической дозой TMP / SMX. У нашего пациента уже был пиелонефрит, вызванный энтерококками, которые были устойчивы к TMP / SMX; однако мы выбрали TMP / SMX в качестве противомикробной профилактики для предотвращения ИМП, вызванных не энтерококками, а грамотрицательными палочками, которые являются первичными уропатогенами даже при рецидивирующих ИМП или тяжелой ПМР. В соответствии с этими условиями мы предположили, что наличие билатерально расширенных мочеточников, вызывающих стойкий застой мочи, позволило выявить S.epidermidis для образования защитной биопленки и усиления ее адгезии к поверхности слизистой оболочки мочеточников. Кроме того, наиболее вероятное объяснение того, почему у нашего пациента развился пиелонефрит, вызванный S. epidermidis , чувствительным к TMP / SMX, независимо от приема CAP с TMP / SMX, заключается в следующем. Обычно простые и сложные сосочки в почках имеют антирефлюксный механизм, который предотвращает попадание мочи из почечной лоханки в собирающие канальцы. Однако некоторые ПМР вызывают внутрипочечный рефлюкс, и впоследствии инфицированная моча стимулирует иммунологический и воспалительный ответ в паренхиме почек, вызывая пиелонефрит [15].Кроме того, поскольку S. epidermidis окружен биопленкой, он может противостоять фагоцитозу и еще больше ухудшать проникновение многих антибиотиков. Следовательно, хотя организмы были восприимчивы к TMP / SMX in vitro , профилактический эффект мог стать слабым in vivo .
При ретроспективном обзоре клинического течения нашего случая мы выделили основные факторы, способствующие возможности заниженного или неправильного диагноза S.epidermidis пиелонефрит. Хотя у нашего пациента не было никаких других симптомов, кроме высокой температуры, а анализ мочи по определению показал пиурию, результаты теста на нитраты были отрицательными, а уровень СРБ как маркера воспаления в сыворотке был повышен лишь незначительно. Следовательно, мы не могли бы заподозрить пиелонефрит при первичном обращении только на основании этих результатов обследования. Однако окрашивание по Граму образцов мочи, полученных в асептических условиях посредством катетеризации, показало значительно положительные грамположительные кокки, что указывало на возможность пиелонефрита.Таким образом, мы эмпирически решили назначать антибиотики. Двумя днями позже его уровень CRP был заметно повышен до 12,2 мг / дл, несмотря на то, что его лихорадка исчезла, а АНК снизились. В конечном итоге было обнаружено, что один S. epidermidis , идентифицированный из пробы мочи, полученной в асептических условиях путем катетеризации, растет со скоростью 10 7 колониеобразующих единиц на миллилитр. На основании этих результатов и ответа на лечение противомикробными препаратами мы подтвердили, что S.epidermidis был уропатогеном. К счастью, мы смогли выбрать антибиотики, подходящие для метициллин-резистентного S. epidermidis . Если бы мы изначально полагали, что присутствие S. epidermidis было связано с загрязнением образца, соответствующая терапия, включая подходящие антибиотики в течение достаточного времени и последующее хирургическое вмешательство, не была бы предоставлена. Кроме того, несоответствующее или недостаточное лечение антибиотиками могло вызвать уросепсис или повреждение почек.Наш случай показывает, что в амбулаторной практике условно-патогенные микроорганизмы, такие как S. epidermidis , могут быть недооценены или неправильно диагностированы, что увеличивает риск неудачи лечения.
Что касается лабораторных данных о пиелонефрите, лейкоцитоз, нейтрофилия и повышенный уровень СРБ являются обычными явлениями в острой фазе пиелонефрита [15]. Однако это неспецифические маркеры бактериальной инфекции, и их повышенный уровень не свидетельствует об остром пиелонефрите [15].Хотя у нашего пациента впервые выявили лейкоцитоз и нейтрофилию при втором пиелонефрите, его уровень СРБ не был значительно повышен (1,81 мг / дл). Однако через два дня после поступления у него уровень СРБ был заметно повышен (12,2 мг / дл), в то время как клинические симптомы улучшились. В некоторых клинических исследованиях изучали значение лабораторных данных, включая CRP, для диагностики острого пиелонефрита у детей (таблица 3) [16–19]. Эти исследования показали, что уровни CRP имеют широкий диапазон и не всегда повышаются даже при остром пиелонефрите.Кроме того, было показано, что, хотя специфичность CRP была низкой, чувствительность была относительно высокой. Кроме того, эти исследования имели важные ограничения. Несмотря на то, что хорошо известно, что на уровень CRP влияет время исследования, время исследования крови с самого начала не было описано. Таким образом, как было замечено у нашего пациента, низкие уровни CRP (особенно ниже 2 мг / дл) не могли исключить острый пиелонефрит, и считалось, что CRP был только одним из «прогностических», но плохих «диагностических» маркеров пиелонефрита.
Таблица 3 Уровни C-реактивного белка (CRP) на момент диагностики, чувствительность, специфичность, положительная (PPV) и отрицательная прогностическая ценность (NPV) CRP для диагностики острого пиелонефрита у детей (пороговые значения 2 мг / дл )Тем не менее, дифференцировать истинную инфекцию S. epidermidis от контаминантов остается сложной задачей. Это связано с тем, что S. epidermidis занимают видное место в комменсальной флоре кожи и слизистых оболочек человека и поэтому часто встречаются в качестве загрязнителей культур.Что касается бактериемии, примерно от 1 до 6% посевов крови загрязнены, а коагулазонегативные стафилококки (обычно S. epidermidis ) являются причиной от 70 до 80% таких случаев [10]. Однако при ИМП эпидемиология контаминантов не очевидна. Следовательно, клиницистам важно знать о возможности « истинной » инфекции S. epidermidis , когда она обнаруживается в посеве мочи, даже в иммунокомпетентных случаях или в случаях без постоянных медицинских устройств, а не просто предполагать, что бактерии представляют собой загрязнение.В таких случаях следует исследовать и оценивать различные клинические и лабораторные параметры, включая методы сбора мочи, изображения мочевыводящих путей и последующий ответ на лечение антибиотиками. Основываясь на клиническом течении нашего случая и обзоре литературы, мы предполагаем, что аномалии мочевыводящих путей являются фактором риска инфекции S. epidermidis при ИМП у детей. Необходимы дальнейшие исследования для определения распространенности ИМП S. epidermidis у детей и факторов, ответственных за развитие ИМП.
Инфекция стафилококка | Johns Hopkins Medicine
Что такое стафилококковая инфекция?
Золотистый стафилококк, или «стафилококк», — это обычные бактерии, которые обычно обитают на коже. Бактерии также безвредно живут в носовых проходах примерно 30 процентов населения США. Стафилококк может вызвать инфекцию, когда попадает на кожу через порез или рану. Заражение также может произойти, когда бактерии перемещаются внутрь тела через катетер или дыхательную трубку.
Золотистый стафилококк, или S.epidermidis, может вызывать стафилококковый менингит, инфекцию оболочек головного и спинного мозга, вызванную: обычно он развивается как осложнение хирургической процедуры или инфекция, передающаяся с кровью.
Диагностика
В зависимости от степени и серьезности ваших симптомов ваш врач может порекомендовать следующие тесты:
Биопсия кожи и посев из инфицированного участка
Посев дренажа (жидкости) от инфекции, чтобы увидеть, какой организм в нем растет
Культура крови
Посев мокроты при кашле или бронхоскопии при наличии или подозрении на пневмонию
Посев мочи при наличии или подозрении на инфекцию мочевыводящих путей
Лечение
Лечение зависит от типа стафилококковой инфекции.Некоторым требуется внутривенное введение антибиотиков. При местной кожной инфекции, вызванной метициллин-резистентным золотистым стафилококком (MRSA), дренирование абсцесса в кабинете врача обычно является единственным необходимым лечением. Для лечения более серьезных инфекций MRSA доступно немного антибиотиков. К ним относятся ванкомицин (Vancocin, Vancoled), триметоприм-сульфаметоксазол (Bactrim, Bactrim DS, Septra, Septra DS) и линезолид (Zyvox).
Примечание: критически важно завершить все введенные вам дозы антибиотиков, даже если вы почувствуете себя лучше перед последней дозой.Незаконченные дозы могут привести к развитию лекарственной устойчивости бактерий.
Выделение Staphylococcus aureus из мочевыводящих путей: связь выделения с симптоматической инфекцией мочевыводящих путей и последующей стафилококковой бактериемией | Клинические инфекционные болезни
Материалы и методы
Пациенты были идентифицированы на основании отчетов микробиологических лабораторий специалистами по инфекционному контролю в ходе рутинных мероприятий по эпиднадзору. Все пациенты, у которых S. aureus было выделено из посевов мочи, заказанных врачами пациентов по клиническим показаниям, были включены в проспективное обсервационное исследование.Культуры ноздрей получали при входе. Клинические изоляты S. aureus были идентифицированы системой Vitek (bioMérieux) с использованием стандартных критериев. Устойчивость к метициллину подтверждали посевом на агар Мюллера-Хинтона с добавлением 4% NaCl и оксациллина, 6 мкг / мл, с последующей инкубацией при 35 ° C в течение 24 часов [13]. Образцы мазков из носа помещали на агар с маннитовой солью; Устойчивость к метициллину S. aureus , выделенного таким образом, была подтверждена, как описано ранее [13].Собранные клинические данные включали демографические характеристики пациентов, исходное местонахождение (например, учреждение долгосрочного ухода, отделение неотложной помощи или дом), основное заболевание (я) и статус катетеризации мочевыводящих путей. Первичный очаг инфекции был классифицирован на основе определений нозокомиальной инфекции Центром по контролю и профилактике заболеваний (CDC) [14]. Однако для диагностики симптоматической инфекции мочевыводящих путей для целей настоящего исследования требовалось извлечение 10 5 бактерий / мл из пробы с мочеиспусканием или 10 4 бактерий / мл из пробы с катетера, никаких клинических доказательств отсутствия — очаг инфекции мочевыводящих путей и минимум 2 из следующих симптомов: температура> 38.5 ° C, изменение психического статуса, макрогематурия, надлобковый дискомфорт, дизурия или боль в боку. Мы намеренно выбрали строгое определение, требующее как минимум 2 симптомов, потому что одна только лихорадка имеет низкую прогностическую ценность в локализации инфекции в мочевыводящих путях у пожилых пациентов с бактериурией [8].
Посев из носа и мочи повторяли каждые 2 месяца до тех пор, пока результаты посева на S. aureus не были отрицательными для 2 последовательных проб или пока пациент не был потерян для последующего наблюдения.Остальные образцы были взяты для посева на усмотрение лечащих пациентов. Пациенты наблюдались на предмет развития инвазивной стафилококковой инфекции в течение всего периода наблюдения. Позднее начало стафилококковой инфекции было определено как инфекция, которая произошла ≥ 7 дней после первоначального положительного результата посева мочи. Антистафилококковая терапия определялась как ванкомицин, вводимый пациенту с метициллин-устойчивой бактериурией S. aureus (MRSA), и как ванкомицин, так и β-лактамный антибиотик, вводимый пациенту с метициллин-чувствительной стафилококковой бактериурией.
Изоляты S. aureus охарактеризовали макрорестрикционным анализом геномной ДНК, расщепленной Sma I, с помощью PFGE. Пробки агарозы бактериальной ДНК переваривали в течение ночи 20 ед. Sma I (New England Biolabs). PFGE выполняли с использованием системы CHEF-DR-II (Bio-Rad). ДНК подвергали электрофорезу в течение 23 ч при 14 ° C в 1% -ном агарозном геле при 6 В / см с временем переключения 5-40 с. Гели окрашивали бромистым этидием и фотографировали при УФ-освещении [15].Штаммы были классифицированы [15] как идентичные (0 различных полос), близкородственные (≤ 3 разных полос), возможно родственные (4–6 разных полос) или несвязанные (≥ 7 разных полос).
Данные пациентов были лишены идентификаторов и введены в компьютерную базу данных. Таблицы непредвиденных обстоятельств были проанализированы с использованием двустороннего критерия χ 2 или точного критерия Фишера. Было сочтено, что исследование не подлежало рассмотрению местным наблюдательным советом учреждения.
Результаты
Мы идентифицировали и включили в исследование 102 последовательных пациента, у которых по крайней мере 1 посев мочи был положительным на S.aureus; В таблице 1 представлены характеристики пациентов. Восемьдесят шесть процентов исходных изолятов стафилококка были MRSA. Все пациенты были мужчинами, что соответствует популяции пациентов по делам ветеранов, средний возраст 72,8 года. Семьдесят процентов были резидентами учреждения длительного ухода, 82% имели мочевой катетер того или иного типа, а 7% недавно перенесли инвазивные процедуры на мочевыводящие пути. Только 11% были с мочой и без мочевыводящего устройства. В таблице 2 показаны клинические данные на момент первоначального положительного результата посева мочи.Тридцать три процента пациентов имели симптоматическую инфекцию мочевыводящих путей, как определено на основе критериев исследования на момент первоначального выделения S. aureus из мочи. 48% пациентов диагностировали инфекцию мочевыводящих путей, поставленную врачом. В таблице 3 показана частота симптомов среди пациентов с диагнозом «инфекция мочевыводящих путей» на основании критериев исследования. Шестнадцать (48%) из 33 пациентов имели по крайней мере 1 новый симптом (гематурия, дизурия, надлобковая боль или боль в боку), специфичных для мочевыводящих путей; 26 (79%) из 33 страдали пиурией.
Таблица 1
Характеристики 102 пациентов на момент их первого положительного посева мочи на Staphylococcus aureus .
Таблица 1
Характеристики 102 пациентов во время их первого положительного посева мочи на Staphylococcus aureus .
Таблица 2
Симптомы при проявлении у 33 пациентов с инфекцией мочевыводящих путей, согласно определению исследования.
Таблица 2
Симптомы при проявлении у 33 пациентов с инфекцией мочевыводящих путей, согласно определению исследования.
Таблица 3
Факторы риска бактериемии во время положительного результата посева мочи на Staphylococcus aureus .
Таблица 3
Факторы риска бактериемии во время положительного результата посева мочи на Staphylococcus aureus .
У 13 пациентов была выявлена бактериемия S. aureus в связи с первым положительным результатом посева мочи. У трех пациентов были положительные результаты посева крови до (за 1-2 дня до этого) образцы мочи для посева, у 6 были положительные результаты посева крови и посев мочи в тот же день, а у 4 были положительные результаты посева крови через 1-4 дня. далее) положительный результат посева мочи. Только 2 пациента получали противомикробные препараты ≤ 14 дней после начала бактериемии.В таблице 2 представлены характеристики пациентов с бактериемией и пациентов без нее. Десять (77%) из 13 пациентов имели катетер мочевого пузыря в начале бактериемии. Пациенты с бактериемией значительно чаще имели гематурию, но это происходило только у одной трети пациентов с бактериемией. Пациенты с бактериурией MRSA не имели значительно большей вероятности развития бактериемии, чем пациенты, инфицированные чувствительными к метициллину изолятами. Первоначальные культуры носовых ходов были выполнены 76 пациентам, 57 (75%) из которых имели носовую колонизацию стафилококками.
Шестнадцать пациентов страдали стафилококковыми инфекциями с поздним началом, то есть инфекциями, которые возникли после первоначального положительного результата посева мочи (от 7 дней до 12 месяцев). У восьми пациентов была обнаружена бактериемия S. aureus с поздним началом, которая возникла через 1–12 месяцев после первоначального посева мочи. Первичными очагами бактериемической инфекции были мочевыводящие пути у 5 пациентов; Образцы крови и мочи для посева были взяты в один и тот же день для всех 5. Пациенты с небактериемическими инфекциями включали 5 пациентов с инфекцией мочевыводящих путей.из 10 пациентов с инфекцией мочевыводящих путей (в том числе 5 с бактериемией) у 7 была пиурия, а у 4 был по крайней мере 1 новый симптом, специфичный для мочевыводящих путей. У всех 5 пациентов с бактериемией были взяты образцы мочи и крови для посева в один и тот же день.
Тринадцать пациентов умерли в течение 30 дней после первоначального посева мочи. из выживших 52% выполнили ≥ 2 дополнительных посевов, 26% выполнили одну дополнительную культуру и 19% были выписаны или иным образом потеряны для последующего наблюдения, и дополнительные посевы не проводились.из 71 пациента, получившего по крайней мере 1 дополнительный посев мочи, у 41 (58%) был по крайней мере 1 положительный посев на S. aureus. Средняя продолжительность колонизации S. aureus составила 4,3 месяца. Пациенты со стойкой колонизацией S. aureus в моче имели более высокую вероятность последующей инфекции, чем пациенты, в моче которых не было S. aureus (34,6% против 10,5%; P = 0,086). У 27 пациентов был проведен как минимум 1 контрольный посев мочи после того, как они получили антистафилококковую терапию антибиотиками.из них 20 (84%) имели отрицательные культуры на S. aureus .
PFGE-типирование было выполнено для исходных изолятов мочи, а также для последующих изолятов крови 7 из 8 пациентов с поздней бактериемией. из них 5 изолятов крови соответствовали изоляту из мочи, при этом 3 пары изолятов кровь / моча были идентичными, а 2 изолятов различались только одной полосой. Три изолята крови отличались от исходного изолята из мочи.
Обсуждение
с.aureus — относительно редко встречающийся изолят мочевыводящих путей среди населения в целом. В многоцентровом исследовании на уровне сообщества, проведенном в Великобритании, S. aureus составляли лишь 0,5% изолятов [2]. Аналогичное лабораторное исследование, проведенное во Франции, показало, что на S. aureus приходилось только 1,3% изолятов из образцов мочи, полученных от местного населения [16]. Предыдущие исследования показывают, что выделение S. aureus из мочи часто является вторичным по отношению к стафилококковой бактериемии, возникающей в другом месте (например,г., при эндокардите) [17]. Таким образом, выделение S. aureus из образцов мочи в отсутствие бактериемии часто рассматривается как колонизация.
Однако в определенных популяциях пациентов S. aureus может быть важным первичным патогеном мочевыводящих путей. Например, инфекция мочевыводящих путей MRSA встречается как эндемически, так и эпидемически среди пациентов, перенесших хирургические хирургические вмешательства [18–20]. Бактериурия MRSA также встречается у пациентов, находящихся на длительном лечении, и в значительной степени связана с катетеризацией мочи и применением антибиотиков [4].Проблематично определить точную роль S. aureus как причины симптоматической инфекции мочевыводящих путей, а не колонизации в этой популяции. У пациентов, находящихся на длительном лечении, часто наблюдается бессимптомная бактериурия [5, 6]. Имеются данные, позволяющие предположить, что большинство эпизодов лихорадки у пациентов с бактериурией, находящихся на длительном лечении, на самом деле не связаны с инфекцией мочевыводящих путей [7, 8]. Кроме того, у пациентов, находящихся на длительном лечении, могут появиться атипичные симптомы в ответ на истинную инфекцию [19].Таким образом, значительная проблема с интерпретацией предшествующих исследований заключается в присущей сложности постановке окончательного диагноза инфекции мочевыводящих путей у лиц, получающих долгосрочное лечение.
Например, Capitano et al. [21] идентифицировали 90 инфекций S. aureus во время ретроспективного когортного исследования в доме престарелых. из них 48% были классифицированы как инфекция мочевыводящих путей с использованием определения лихорадки (температура> 37,5 ° C) в сочетании со стафилококковой бактериурией.Как отмечалось выше, это определение инфекции мочевыводящих путей имеет низкую специфичность в популяции лиц, нуждающихся в длительном лечении. В наблюдательном когортном исследовании Pacio et al. [22] сообщили, что у 13% пациентов длительного лечения, колонизированных MRSA в любом месте, развилась симптоматическая инфекция мочевыводящих путей. Не было дано определения инфекции мочевыводящих путей, и молекулярное типирование для подтверждения идентичности первоначального колонизирующего и последующего заражающего штаммов не проводилось.
Есть данные, что S.aureus является основным возбудителем мочевыводящих путей в этой популяции. Используя критерии CDC для внутрибольничной инфекции для определения инфекции мочевыводящих путей, мы обнаружили, что 4% случаев бактериемии мочевыводящих путей среди пациентов длительного лечения были вызваны S. aureus [10]. В последующем исследовании госпитализированных пациентов домов престарелых Mylotte et al. [12] сообщили, что 11% эпизодов бактериемии с инфекцией мочевыводящих путей в качестве предполагаемого источника были вызваны MRSA, что было определено на основе симптомов и сопутствующего выделения MRSA из образцов мочи.Специфические симптомы мочевыводящих путей, подтверждающие диагноз инфекции мочевыводящих путей, не приводились.
В нашем проспективном исследовании 102 пациентов с бактериурией S. aureus мы использовали априорное определение инфекции мочевыводящих путей, которое требовало наличия как минимум 2 клинических показателей инфекции. Мы намеренно использовали более ограничительное определение инфекции, чем то, которое используется при описании внутрибольничной инфекции, из-за трудности дифференциации бессимптомной бактериурии от инфекции мочевыводящих путей у пожилых людей и у лиц с установленными постоянными катетерами.Даже с использованием строго ограничительного определения мы обнаружили, что у одной трети пациентов (33 из 102) с бактериурией S. aureus имелись признаки первичной инфекции мочевыводящих путей, а у одной трети (13 из 33) этих пациентов была бактериемия. презентация. Кроме того, мы обнаружили, что среди пациентов, у которых была стойкая стафилококковая бактериурия, 14 (34%) из 41 имели последующую стафилококковую инфекцию. из них у 12 были случаи, которые были классифицированы как инфекция мочевыводящих путей на основании нашего априорного определения.Шесть поздних инфекций (43%) у этих пациентов были связаны с бактериемией. PFGE-типирование исходных изолятов и последующих изолятов, связанных с инфекцией, показало, что исходный и последующие изоляты были идентичны или тесно связаны у 5 из 7 пациентов, изоляты которых были типированы. Таким образом, мы документально подтверждаем, что в популяции длительного лечения мочевыводящие пути, которые постоянно колонизированы S. aureus , могут быть важным очагом для последующего возникновения стафилококковой инфекции.Этот риск, по-видимому, больше, чем риск, связанный только с колонизацией ноздрей. В предыдущем исследовании, проведенном в том же медицинском центре, мы отметили, что частота инфекций, связанных со стойкой колонизацией носовых ходов MRSA, составляла 25% [23].
Эти результаты имеют важное значение для ухода за пациентами. Поскольку катетеризация мочи является основным фактором риска бактериурии S. aureus , сокращение распространенности катетеризации должно быть полезным. Усилия по ограничению приобретения MRSA катетеризованными пациентами с помощью соответствующих мер инфекционного контроля и ограничения ненужного введения антибиотиков оправданы в учреждениях долгосрочного ухода.
Учитывая высокий риск последующей инфекции у пациентов, чья моча постоянно колонизирована S. aureus , уместно поставить под вопрос, может ли устранение колонизации MRSA у этих пациентов быть полезным. В общей популяции пациентов длительного лечения с колонизацией ноздрей MRSA применение мупироцина в ноздри не показало значительного снижения риска инфекции MRSA [24]. Маловероятно, что интраназальный мупироцин в любом случае будет иметь какое-либо влияние на колонизацию мочи.Системная терапия антимикробными препаратами, которые выделяются с мочой, является возможным подходом, но результаты ограниченных клинических испытаний с участием этой группы пациентов неутешительны. Например, комбинация рифампицина и миноциклина имела высокую частоту неудач в отношении эрадикации MRSA у пациентов, находящихся на длительном лечении; возникла устойчивость как к рифампицину, так и к миноциклину [25].
Наше исследование имеет некоторые потенциальные ограничения. Во-первых, для первоначального выявления стафилококковой бактериурии необходимо, чтобы образец мочи был взят по распоряжению врача.Таким образом, идентифицированная популяция пациентов могла отличаться от той, которая была идентифицирована при систематическом наблюдении за всеми пациентами на S. aureus в моче. Во-вторых, не всем пациентам со стафилококковой бактериурией проводились сопутствующие посевы крови; некоторые случаи бактериемии могли быть пропущены. Мы отмечаем, что это привело бы к недооценке важности мочевыводящих путей как источника бактериемии S. aureus .
Таким образом, наше исследование показывает, что S.aureus — и в частности MRSA — является основным патогеном мочевыводящих путей среди пациентов, находящихся на длительном лечении. Одна треть пациентов с бактериурией MRSA имеет симптоматическую инфекцию мочевыводящих путей при поступлении, а одна треть этих пациентов имеет сопутствующую бактериемию. Стойкая колонизация мочевыводящих путей связана с высоким риском последующей инфекции и бактериемии. У пациентов с лихорадкой или сепсисом предыдущее выявление колонизации мочевыводящих путей S. aureus может быть полезным при выборе эмпирической антимикробной терапии.Это исследование демонстрирует, что концентрация внимания на моче как потенциальном резервуаре инфекции может быть эффективной стратегией профилактики.
Благодарности
Мы благодарим Ларри М. Баддура, Кента Кроссли и Дэниела М. Мушера за их ценные обзоры рукописи.
Возможный конфликт интересов . Все авторы: без конфликтов.
Список литературы
1,,.Staphylococcus aureus bacteriuria
,Arch Intern Med
,1979
, vol.139
(стр.78
—80
) 2,,,,,.Чувствительность к антибиотикам бактерий, ассоциированных с внебольничной инфекцией мочевыводящих путей в Великобритании
,J Antimicrob Chemother
,1999
, vol.44
(стр.359
—65
) 3,,.Связь между бактериемией Staphylococcus aureus и бактериурией
,Am J Med
,1978
, vol.65
(стр.303
—6
) 4,,,.Клинические факторы риска метициллин-резистентной Бактериурия Staphylococcus aureus в доме престарелых с квалифицированным уходом
,Arch Fam Med
,1994
, vol.3
(стр.357
—60
) 5.Бактериальные изменения в образцах мочи пациентов с длительно установленными катетерами
,Arch Intern Med
,1984
, vol.144
(стр.1585
—8
) 6,,,,,.Лихорадка, бактериемия и смерть как осложнения бактериурии у женщин с длительными уретральными катетерами
,J Infect Dis
,1987
, vol.155
(стр.1151
—8
) 7,,,.Локализация инфекции мочевыводящих путей у пожилых, госпитализированных женщин с бессимптомной бактериурией
,J Infect Dis
,1988
, vol.157
(стр.65
—70
) 8« et al.Фебрильная инфекция мочевыводящих путей у пожилых людей в специализированных учреждениях
,Am J Med
,1996
, vol.100
(стр.71
—7
) 9.Инфекция мочевыводящих путей у пациентов стационара
,Clin Infect Dis
,2000
, vol.31
(стр.757
—61
) 10,,,.Бактериемия в учреждении длительного ухода: пятилетнее проспективное исследование 163 последовательных эпизодов
,Clin Infect Dis
,1992
, vol.14
(стр.647
—54
) 11,.Клиническое значение золотистого стафилококка бактериурия
,Дж Урол
,1984
, т.132
(стр.697
—700
) 12,,.Эпидемиология инфекции кровотока у жителей домов престарелых: оценка в большой когорте из нескольких домов
,Clin Infect Dis
,2002
, vol.35
(стр.1484
—90
) 13,.Успешное использование микроразведений бульона в тестах на чувствительность к метициллин-резистентным (гетерорезистентным) стафилококкам
,J Clin Microbiol
,1983
, vol.18
(стр.1084
—91
) 14,,,,.Определения CDC для нозокомиальных инфекций, 1988
,Am J Infect Control
,1988
, vol.16
(стр.128
—40
) 15« и др.Интерпретация паттернов рестрикции хромосомной ДНК, полученных с помощью гель-электрофореза в импульсном поле: критерии типирования бактериального штамма
,J Clin Microbiol
,1995
, vol.33
(стр.2233
—9
) 16.Чувствительность к антибиотикам бактериальных штаммов, выделенных от пациентов с внебольничными инфекциями мочевыводящих путей во Франции
,Eur J Clin Microbiol Infect Dis
,2000
, vol.19
(стр.112
—7
) 17,.Инфекции, вызванные Staphylococcus aureus
,Лекарство
,1977
, т.56
(стр.383
—409
) 18,,,,.Молекулярно-эпидемиологические исследования Staphylococcus aureus при инфекциях мочевыводящих путей
,J Infect Chemother
,2002
, vol.8
(стр.168
—74
) 19,,,.Вспышка MRSA в отделении мочеиспускания и ее связь с лечением простаты коагуляционным лазером Nd: YAG
,J Hosp Infect
,1999
, vol.41
(стр.39
—44
) 20,,,,,.Практическое руководство по оценке лихорадки и инфекции в учреждениях длительного ухода
,J Am Geriatr Soc
,2001
, vol.49
(стр.210
—22
) 21,,,.Рентабельность лечения метициллин-резистентных Staphylococcus aureus в учреждении длительного ухода
,J Am Geriatr Soc
,2003
, vol.51
(стр.10
—6
) 22,,,,,.Естественная история колонизации устойчивых к ванкомицину энтерококков, метициллин-устойчивых Staphylococcus aureus и устойчивых грамотрицательных бацилл среди пациентов стационара
,Infect Control Hosp Epidemiol
,2003
, vol.24
(стр.246
—50
) 23« и др.Колонизация и инфекция устойчивых к метициллину стафилококков в учреждении длительного ухода
,Ann Intern Med
,1991
, vol.114
(стр.107
—12
) 24,,,,.Деколонизация Staphylococcus aureus на основе мупироцина у пациентов в 2 учреждениях длительного ухода: рандомизированное двойное слепое плацебо-контролируемое исследование
,Clin Infect Dis
,2003
, vol.37
(стр.1467
—74
) 25« и др.Контролируемое испытание рифампицина, миноциклина и рифампицина плюс миноциклин для эрадикации метициллин-резистентного Staphylococcus у пациентов длительного лечения
,J Antimicrob Chemother
,1994
, vol.34
(стр.189
—90
)© 2005 Американского общества инфекционистов
Staphylococcus aureus Инфекция кровотока, исходящая из мочевыводящих путей: характеристики и 30-дневная смертность
Staphylococcus aureus является одновременно комменсальным организмом, колонизирующим кожу и верхние дыхательные пути, и патогеном человека, вызывающим широкий спектр инфекций от довольно доброкачественных инфекций кожи и мягких тканей до опасных для жизни состояний, таких как бактериемия и эндокардит. S. aureus — нечастая причина инфекции мочевыводящих путей в общей популяции, на которую приходится 0,4% -4% положительных посевов мочи. 1-3
S . Бактериурия aureus (SABU) чаще встречается у пациентов с постоянными катетерами мочевыводящих путей или предшествующими инструментами для мочевыводящих путей 4 и может отражать колонизацию мочевыводящих путей только у бессимптомных лиц. Однако при выделении из мочи без явного мочевого фокуса SABU может быть маркером гематогенного засева мочевыводящих путей с предполагаемой распространенностью 7–16% у пациентов с S .aureus инфекция кровотока (SABSI). 5-7 Инфекция кровотока S. aureus из источника мочевыводящих путей (SABSI-UTS) является нечастым осложнением инфекции мочевыводящих путей S. aureus и составляет лишь 3-6% пациентов с SABSI. 8,9 Интерпретация частоты SABSI-UTS была сложной задачей, учитывая трудности приписывания эпизода SABSI источнику мочевыводящих путей и вариации в определении этого синдрома.
Грилло и его коллеги провели многоцентровое ретроспективное когортное исследование взрослых пациентов, госпитализированных с SABSI, для определения характеристик и 30-дневной смертности пациентов с SABSI-UTS. 10 В этом исследовании исследователи определили SABSI как наличие по крайней мере одного положительного посева крови, полученного у пациента с признаками и симптомами инфекции. SABSI-UTS был диагностирован у пациентов с SABSI и наличием признаков / симптомов со стороны мочевыводящих путей, отсутствием вероятного внемочечного источника инфекции и посевом мочи, увеличивающим ≥ 105 колониеобразующих единиц / мл.
Из 4181 эпизода SABSI исследователи выявили 132 (3,16%) случая SABSI-UTS, аналогично оценкам предыдущих исследований. 8,9 Среди пациентов с SABSI-UTS 116 (87,9%) были мужчинами, средний возраст составлял 70 лет, а средний балл коморбидности по Чарлсону составлял 5 баллов. 104 (78,7%) инфекций были классифицированы как внутрибольничные или связанные с оказанием медицинской помощи, а 28 (21,2%) инфекций были внебольничными. Постоянные мочевые катетеры присутствовали у 94 (71,2%) пациентов, а манипуляции с мочеиспусканием (например, смена катетера, хирургическое вмешательство) произошли у 85 (64,4%) пациентов до начала SABSI, со средним временем от манипуляции до бактериемии 9. дней.
Восприимчивость к S . aureus и 30-дневная смертность пациентов, определяемая как смерть по любой причине в течение 30 дней после начала бактериемии, сравнивали между пациентами с SABSI-UTS и пациентами с SABSI из другого источника. Исследователи обнаружили, что SABSI-UTS чаще вызывается метициллин-устойчивым Staphylococcus aureus (MRSA) по сравнению с SABSI из не мочевыводящих путей (40,9% против 17,5%, P <0,001). 30-дневная смертность была значительно ниже у пациентов с SABSI-UTS по сравнению с пациентами с SABSI из источника, не связанного с мочевыводящими путями (14.4% против 23,8%, P = 0,02). Пациенты с SABSI-UTI, вызванной MRSA, получали адекватную эмпирическую антибактериальную терапию реже по сравнению с пациентами с метициллин-чувствительными штаммами (40,3% против 79,6%, P <0,001), однако не было значительных различий в смертности между группами ( Смертность 18,5% (10 из 54) при MRSA против 11,5% (9 из 78) смертности при MSSA, P = 0,261). Разница в смертности между группами могла не быть обнаружена из-за небольшого размера выборки и небольшого количества смертей.
При многомерном анализе пациенты, которые зависели от повседневной активности (скорректированное отношение шансов [AOR], 3,9; 95% ДИ, 1,2-13,8) или имели стойкую бактериемию, определяемую как длительность бактериемии ≥3 дней после соответствующей противомикробной терапии, (AOR, 7,9; 95% ДИ, 1,6-39,5) имели повышенные шансы 30-дневной смертности с поправкой на возраст> 70 лет и оценку коморбидности Чарлсона> 5 баллов.
Результаты этого исследования имеют важное значение для ухода за пациентами. Хотя это и редко, клиницисты должны признать, что S.Инфекция кровотока aureus может быть напрямую связана с мочевыводящими путями. Недавняя катетеризация мочевыводящих путей и / или манипуляции с мочевыводящими путями могут быть факторами риска развития инфекции мочевыводящих путей S. aureus и последующей инфекции кровотока. Поскольку MRSA был причиной 40% SABI-UTI, клиницистам следует рассмотреть возможность эмпирического охвата MRSA пациентов с возможной инфекцией кровотока S. aureus из мочевыводящих путей. Наконец, это исследование подчеркивает еще одну причину важности сокращения использования катетеризации мочи и манипуляций только для лиц с четкими показаниями для этого.
Полли ван ден Берг, доктор медицины, в настоящее время второй год работает научным сотрудником по инфекционным заболеваниям в Медицинском центре Beth Israel Deaconess в Бостоне, Массачусетс. Ее клинические интересы включают инфекционный контроль и применение антимикробных препаратов.
Особое исследование: Grillo S, Cuervo G, Carratalà J, et al. Характеристики и исходы инфекции кровотока Staphylococcus aureus, исходящей из мочевыводящих путей: многоцентровое когортное исследование. Открытый форум Infect Dis. 2020; 7 (7): ofaa216.
Список литературы
- Арпи М., Реннеберг Дж. Клиническое значение бактериурии золотистого стафилококка. Дж Урол . 1984; 132 (4): 697-700
- Demuth PJ, Gerding DN, Crossley K. Staphylococcus aureus bacteriuria. Arch Intern Med . 1979; 139 (1): 78-80.
- Al Mohajer M, Musher DM, Minard CG, Darouiche RO. Клиническое значение бактериурии золотистого стафилококка в больнице третичного уровня. Scand J Infect Dis . 2013; 45 (9): 688-695.
- Караконстантис С., Калемаки Д. Оценка и лечение бактериурии золотистого стафилококка: обновленный обзор. Инфекция . 2018; 46 (3): 293-301.
- Асгейрссон Х., Кристьянссон М., Кристинссон К.Г., Гудлаугссон О. Клиническое значение бактериурии золотистого стафилококка в общенациональном исследовании взрослых с бактериемией, вызванной S. aureus. J Заразить . 2012; 64 (1): 41-46.
- Стокс В., Паркинс Мэриленд, Парфитт ЭСТ, Руис Дж. К., Магфорд Дж., Грегсон Д.Б.Заболеваемость и исходы бактериурии Staphylococcus aureus: популяционное исследование. Clin Infect Dis . 2019; 69 (6): 963-969.
- Караконстантис С., Калемаки Д. Клиническое значение сопутствующей бактериурии у пациентов с бактериемией Staphylococcus aureus. Обзор и метаанализ. Infect Dis (Лондон) . 2018; 50 (9): 648-659.
- Jacobsson G, Gustafsson E, Andersson R. Исход инвазивных инфекций Staphylococcus aureus. евро J Clin Microbiol Infect Dis . 2008; 27 (9): 839-848.
- Бенфилд Т., Эсперсен Ф., Фримодт-Мёллер Н. и др. Увеличение заболеваемости, но снижение внутрибольничной смертности от бактериемии взрослых Staphylococcus aureus в период с 1981 по 2000 год. Clin Microbiol Infect . 2007; 13 (3): 257-263.
- Grillo S, Cuervo G, Carratalà J и др. Характеристики и исходы Staphylococcus aureus Инфекция кровотока из мочевыводящих путей: многоцентровое когортное исследование. Открытый форум Infect Dis . 2020; 7 (7): ofaa216.
Золотистый стафилококк Бактериурия: какое значение? | 2019-10-19 | Relias Media
Автор Ричард Р. Уоткинс , MD, MS, FACP, FIDSA
Профессор внутренней медицины, Медицинский университет Северо-Восточного Огайо; Отделение инфекционных заболеваний, Кливлендская клиника Акрон Дженерал, Акрон, Огайо
Д-р Уоткинс сообщает об отсутствии финансовых отношений, относящихся к этой области исследования.
СИНОПСИС: В ретроспективном исследовании, проведенном в Канаде, исследователи сообщили о нескольких факторах риска серьезных инфекций Staphylococcus aureus , включая бактериемию и вертебральный остеомиелит, у пациентов с бактериурией S. aureus .
ИСТОЧНИК: Stokes W, Parkins MD, Parfitt ECT, et al. Заболеваемость и исходы бактериурии Staphylococcus aureus : популяционное исследование. Clin Infect Dis 2019; 69: 963-969.
S taphylococcus aureus бактериурия (SABU) — частая клиническая головоломка. Он редко вызывает инфекции мочевыводящих путей и обычно представляет собой колонизацию мочи, особенно у пациентов с постоянными катетерами Фолея. Однако SABU может быть зловещим признаком серьезной инфекции, такой как бактериемия S. aureus (SAB) или скрытый абсцесс. Таким образом, Stokes и его коллеги стремились определить характеристики, связанные с SABU, которые устанавливают более высокий риск системной инфекции.
В исследование были включены все посевы мочи от пациентов в возрасте ≥ 18 лет с положительным результатом на S. aureus в период с 1 января 2010 г. по 31 декабря 2013 г. из централизованной лаборатории в Калгари. Исследователи исключили посевы мочи с разницей в три месяца и с одной и той же антибиотикограммы, поскольку предполагалось, что это рецидивы исходной инфекции. Исследователи включали посевы крови и культуры из стерильной жидкости, ткани, оборудования, наконечников катетеров и глубоких абсцессов в анализ, если они произошли в течение трех месяцев после любого SABU.Из-за неполных данных исследователи исключили лабораторные данные из многомерного регрессионного анализа.
Из более чем 800 000 посевов мочи, собранных в течение периода исследования, 3739 (0,4%) выросли S. aureus. После исключения в анализ были включены 2540 культур от 2054 пациентов. По сравнению с населением Калгари в целом, SABU чаще встречается у мужчин и у пожилых пациентов (то есть от 60 до 85 лет, средний возраст 74 года). Диабет был в два раза чаще у пациентов с SABU, чем в общей популяции, и даже выше у пациентов с SABU и SAB.По сравнению с пациентами с SABU, пациенты с SABU и SAB с большей вероятностью были моложе, были госпитализированы, недавно перенесли урологическую процедуру и имели чистую культуру S. aureus (т. Е. Не смешанную).
Дополнительные факторы риска, связанные с SABU и SAB, включали наличие незрелых нейтрофилов, сывороточных тромбоцитов <120, сывороточных лейкоцитов> 15000, стационарного статуса, процедуры мочеиспускания, мужского пола и чистого S. aureus посев мочи. Наиболее частыми источниками выявленной бактериемии были остеомиелит позвоночника или таза (23% случаев) и инфекционный эндокардит (11% случаев).
Факторами, защищающими от SAB, были деменция, уровень лейкоцитов в моче> 10 клеток / hpf, стойкий SABU, возраст> 65 лет и наличие нитритов в моче. При оценке САБ у амбулаторных пациентов с САБУ уровень лейкоцитов> 15000 был связан с более высоким риском, наряду с диабетом и наличием мочевого катетера. Проживание в доме престарелых было связано с более низким риском, но деменция, возраст> 65 лет и недавняя урологическая процедура не повлияли на частоту САБ среди амбулаторных пациентов с САБУ.Наконец, повышенный уровень С-реактивного белка был идентифицирован как предиктор SAB с SABU при одномерном анализе, но не при многомерном анализе из-за нечастого тестирования.
КОММЕНТАРИЙ
Это крупнейшее исследование по оценке связи между SABU и SAB. Выявленные факторы риска должны помочь клиницистам определить значимость SABU и необходимость дальнейшего обследования. Примечательно, что SABU, обнаруженный за ≥ 48 часов до SAB, был связан с более высоким риском смерти по сравнению с теми, у кого одновременно диагностировали SAB и SABU.Этот вывод подчеркивает важность быстрого определения SAB при обнаружении SABU. Как отметили авторы, микробиологические лаборатории должны играть активную роль в распространении информации о значении SABU, особенно при его первом обнаружении.
Обнаружение SABU особенно сложно в амбулаторных условиях. В этой группе пациентов клиницисты не могут позволить себе тщательного обследования и наблюдения, которые доступны в стационарных условиях. Интересно, что наличие мочевого катетера было фактором риска САБ у амбулаторных пациентов, но не у стационарных.Вероятное объяснение состоит в том, что использование мочевых катетеров у госпитализированных пациентов является временной мерой, более часто по сравнению с амбулаторными пациентами, для которых катетер, скорее всего, будет хроническим. Таким образом, существует повышенный риск осложнений, таких как восходящая инфекция мочевыводящих путей.
Из пациентов с САБУ и САБ у большого числа были инфекции позвоночника. Предыдущие исследования документально подтвердили повышенный риск остеомиелита из-за грамотрицательных патогенов в моче, особенно среди пожилых людей с бактериурией.Считается, что это явление связано с соединением венозных сетей между тазом, позвоночником и мочевым пузырем. Поэтому при обнаружении SABU необходимо провести подробный анамнез и провести обследование у врача на предмет остеомиелита позвоночника.
У исследования было несколько ограничений. Как и во всех ретроспективных исследованиях, неизмеряемые искажающие переменные могли повлиять на наблюдаемые уровни заболеваемости и смертности. Неясно, действительно ли повышенный уровень СРБ связан с SAB у пациентов с SABU из-за небольшого количества результатов тестов (n = 39).На это можно ответить путем дальнейшего расследования. Наконец, смерть была определена как произошедшая во время госпитализации, поэтому те, кто умер вне больницы, не были бы обнаружены.
Несмотря на эти недостатки, это исследование предоставляет полезные данные, которые должны быть полезны клиницистам, когда они размышляют о значении SABU. Микробиологические лаборатории должны рассмотреть возможность добавления к отчету о культуре того, что SABU может представлять тяжелое системное заболевание и что рекомендуется клиническая корреляция.
Инфекции мочевыводящих путей: эпидемиология, механизмы заражения и варианты лечения
Стамм, У. Э. и Норрби, С. Р. Инфекции мочевыводящих путей: обзор болезней и проблемы. J. Infect. Дис. 183 (Дополнение 1), S1 – S4 (2001).
PubMed Google Scholar
Schappert, S. M. & Rechtsteiner, E. A. Оценка использования амбулаторной медицинской помощи за 2007 г. Vital Health Stat. 13 , 1–38 (2011).
Google Scholar
Фоксман, Б. Синдромы инфекций мочевыводящих путей: возникновение, рецидивы, бактериология, факторы риска и бремя болезней. Заражение. Дис. Clin. North Am. 28 , 1–13 (2014). В этом документе представлена самая последняя информация об ИМП и их социально-экономическом воздействии.
PubMed Google Scholar
Фоксман, Б.Эпидемиология инфекции мочевыводящих путей. Nature Rev. Urol. 7 , 653–660 (2010).
Google Scholar
Хутон, Т. М. Неосложненная инфекция мочевыводящих путей. New Engl. J. Med. 366 , 1028–1037 (2012).
CAS PubMed Google Scholar
Ниелубович, Г. Р. и Мобли, Х. Л. Взаимодействие между хозяином и патогеном при инфекции мочевыводящих путей. Nature Rev. Urol. 7 , 430–441 (2010). В этом обзоре сравниваются стратегии, используемые двумя важными уропатогенами, E. coli и P. mirabilis , реакция хозяина на каждый патоген, а также текущие методы лечения и терапии для предотвращения ИМП.
CAS Google Scholar
Hannan, T. J. et al. Контрольные точки «хозяин – патоген» и узкие места среди населения при стойкой и внутриклеточной уропатогенной инфекции мочевого пузыря Escherichia coli . FEMS Microbiol. Ред. 36 , 616–648 (2012).
CAS PubMed PubMed Central Google Scholar
Лихтенбергер, П. и Хутон, Т. М. Осложненные инфекции мочевыводящих путей. Curr. Заразить. Дис. Реп. 10 , 499–504 (2008).
PubMed Google Scholar
Левисон М. Э. и Кей Д. Лечение осложненных инфекций мочевыводящих путей с упором на лекарственно-устойчивые грамотрицательные уропатогены. Curr. Заразить. Дис. Док. 15 , 109–115 (2013).
PubMed Google Scholar
Lo, E. et al. Стратегии профилактики катетер-ассоциированных инфекций мочевыводящих путей в больницах неотложной помощи: обновление 2014 г. Заражение. Control Hosp. Эпидемиол. 35 , 464–479 (2014).
PubMed Google Scholar
Ченовет, К.Э., Гулд, К. В. и Сент, С. Диагностика, лечение и профилактика катетер-ассоциированных инфекций мочевыводящих путей. Заражение. Дис. Clin. North Am. 28 , 105–119 (2014).
PubMed Google Scholar
Клайн, К. А., Шварц, Д. Дж., Льюис, В. Г., Халтгрен, С. Дж. И Льюис, А. Л. Активация и подавление иммунитета стрептококком группы В на мышиной модели инфекции мочевыводящих путей. Заражение. Иммун. 79 , 3588–3595 (2011).
CAS PubMed PubMed Central Google Scholar
Рональд А. Этиология инфекции мочевыводящих путей: традиционные и новые патогены. Am. J. Med. 113 (Дополнение 1A), 14S – 19S (2002).
PubMed Google Scholar
Фишер, Дж. Ф., Кавана, К., Собел, Дж.Д., Кауфман, К. А. и Ньюман, К. А. Candida Инфекция мочевыводящих путей: патогенез. Clin. Заразить. Дис. 52 (Приложение 6), S437 – S451 (2011).
PubMed Google Scholar
Чен, Ю. Х., Ко, В. К. и Сюэ, П. Р. Возникающие проблемы резистентности и будущие перспективы фармакотерапии осложненных инфекций мочевыводящих путей. Мнение эксперта. Фармакотер. 14 , 587–596 (2013). В этой статье подчеркивается возникающая устойчивость среди бактериальных патогенов, проблемы, с которыми мы сталкиваемся в борьбе с этими устойчивыми бактериями, и потенциальные эффективные средства для лечения ИМП, вызванных патогенами с множественной лекарственной устойчивостью.
PubMed Google Scholar
Якобсен, С. М., Стиклер, Д. Дж., Мобли, Х. Л. и Шертлифф, М. Е. Осложненные катетер-ассоциированные инфекции мочевыводящих путей, вызванные Escherichia coli и Proteus mirabilis . Clin. Microbiol. Ред. 21 , 26–59 (2008).
CAS PubMed PubMed Central Google Scholar
Костакиоти, М., Халтгрен, С. Дж. И Хаджифрангискоу, М. Молекулярный план уропатогенной вирулентности Escherichia coli дает ключи к разработке терапевтических средств против вирулентности. Вирулентность 3 , 592–594 (2012).
PubMed PubMed Central Google Scholar
Субащандраноза, С.и другие. Хозяин-специфическая индукция генов пригодности Escherichia coli во время инфекции мочевыводящих путей человека. Proc. Natl Acad. Sci. США 111 , 18327–18332 (2014).
Google Scholar
Ханделвал П., Абрахам С. Н. и Аподака Г. Клеточная биология и физиология уроэпителия. Am. J. Physiol. Renal Physiol. 297 , F1477 – F1501 (2009).
CAS PubMed PubMed Central Google Scholar
Ли, Г.Уроплакины нижних мочевыводящих путей. Внутр. Neurourol. J. 15 , 4–12 (2011).
PubMed PubMed Central Google Scholar
Это, Д. С., Джонс, Т. А., Сундсбак, Дж. Л. и Малви, М. А. Инвазия клеток-хозяев, опосредованная интегрином, уропатогенными уропатогенными клетками типа 1 Escherichia coli . PLoS Pathog. 3 , e100 (2007).
PubMed PubMed Central Google Scholar
Ниведита, С., Прамодхини, С., Умадеви, С., Кумар, С. и Стивен, С. Выделение и образование биопленок уропатогенов у пациентов с катетер-ассоциированными инфекциями мочевыводящих путей (ИМП). J. Clin. Диаг. Res. 6 , 1478–1482 (2012).
CAS PubMed PubMed Central Google Scholar
Якобсен, С. М. и Шертлифф, М. Е. Proteus mirabilis , биопленки и катетер-ассоциированные инфекции мочевыводящих путей. Вирулентность 2 , 460–465 (2011). В этой статье кратко описаны этапы образования кристаллической биопленки P. mirabilis во время CAUTI.
PubMed Google Scholar
Клайн, К. А., Додсон, К. В., Капарон, М. Г. и Халтгрен, С. Дж. Рассказ о двух пили: сборка и функция пилей у бактерий. Trends Microbiol. 18 , 224–232 (2010).
CAS PubMed PubMed Central Google Scholar
Вурпель, Д. Дж., Битсон, С. А., Тоцика, М., Петти, Н. К. и Шембри, М. А. Шаперон-ашер-фимбрии Escherichia coli . PLoS ONE 8 , e52835 (2013 г.).
CAS PubMed PubMed Central Google Scholar
Ваксман, Г. и Халтгрен, С. Дж.Структурная биология шаперон-ашерного пути биогенеза пилуса. Nature Rev. Microbiol. 7 , 765–774 (2009). В этом обзоре представлено самое актуальное и глубокое понимание того, как собираются пили посредством пути шаперон-ашер.
CAS Google Scholar
Валле, И., Олсон, Дж. У., Лори, С., Лаздунски, А. и Филлу, А. Шаперонные / вспомогательные пути Pseudomonas aeruginosa : идентификация кластеров фимбриальных генов ( чашки ) и их участие в формировании биопленок. Proc. Natl Acad. Sci. США 98 , 6911–6916 (2001).
CAS PubMed Google Scholar
Chorell, E. et al. Картирование антивирулентного эффекта пилицида в Escherichia coli , всестороннее исследование структуры и активности. Bioorg. Med. Chem. 20 , 3128–3142 (2012).
CAS PubMed PubMed Central Google Scholar
Танасси, Д.Г., Саулино, Э. Т. и Халтгрен, С. Дж. Путь шаперона / помощника: основная конечная ветвь общего секреторного пути. Curr. Opin. Microbiol. 1 , 223–231 (1998).
CAS PubMed Google Scholar
Piatek, R. et al. Пилициды ингибируют FGL-шаперон / ашер-ассистируемый биогенез фимбриального полиадгезина Dr из уропатогенной Escherichia coli . BMC Microbiol. 13 , 131 (2013). В этой статье представлен краткий обзор двух схожих путей сборки пилуса CUP и показано, что антивирулентные соединения (пилициды), которые были первоначально разработаны для целенаправленного воздействия на один путь, обладают активностью широкого спектра против обоих путей CUP пилуса в E. coli .
CAS PubMed PubMed Central Google Scholar
Dang, H. T. et al. Синтезы и биологическая оценка производных 2-амино-3-ацилтетрагидробензотиофена; антибактериальные средства с противовирулентной активностью. Org. Biomol. Chem. 12 , 1942–1956 (2014).
PubMed PubMed Central Google Scholar
Гейбель, С., Прокко, Э., Халтгрен, С. Дж., Бейкер, Д. и Ваксман, Г. Структурная и энергетическая основа транспорта свернутых белков с помощью помощника FimD. Природа 496 , 243–246 (2013).
CAS PubMed PubMed Central Google Scholar
Райт, К.Дж. И Халтгрен, С. Дж. Липкие волокна и уропатогенез: бактериальные адгезины в мочевыводящих путях. Future Microbiol. 1 , 75–87 (2006).
CAS PubMed Google Scholar
Hadjifrangiskou, M. et al. Мутагенез транспозонов идентифицирует уропатогенные факторы биопленки Escherichia coli . J. Bacteriol. 194 , 6195–6205 (2012).
CAS PubMed PubMed Central Google Scholar
Гитон, П.S. et al. Комбинаторная низкомолекулярная терапия предотвращает уропатогенные Escherichia coli катетер-ассоциированные инфекции мочевыводящих путей у мышей. Антимикробный. Агенты Chemother. 56 , 4738–4745 (2012).
CAS PubMed PubMed Central Google Scholar
Мартинез, Дж. Дж. И Халтгрен, С. Дж. Потребность в ГТФазах семейства Rho при инвазии уропатогенных возбудителей типа 1 Escherichia coli . Cell. Microbiol. 4 , 19–28 (2002).
CAS PubMed Google Scholar
Song, J. et al. TLR4-опосредованное изгнание бактерий из инфицированных эпителиальных клеток мочевого пузыря. Proc. Natl Acad. Sci. США 106 , 14966–14971 (2009).
CAS PubMed Google Scholar
Андерсон, Г. Г. и др. Внутриклеточные бактериальные стручки, похожие на биопленку, при инфекциях мочевыводящих путей. Наука 301 , 105–107 (2003). Это первая статья, в которой описывается внутриклеточный цикл уропатогена и его значение для устойчивости.
CAS PubMed Google Scholar
Ханнан, Т. Дж., Майсорекар, И. У., Хунг, С. С., Исааксон-Шмид, М. Л. и Халтгрен, С. Дж. Ранние тяжелые воспалительные реакции на уропатогенную кишечную палочку E. coli предрасполагают к хронической и рецидивирующей инфекции мочевыводящих путей. PLoS Pathog. 6 , e1001042 (2010).
PubMed PubMed Central Google Scholar
Костакиоти, М., Хаджифрангискоу, М. и Халтгрен, С. Дж. Бактериальные биопленки: развитие, распространение и терапевтические стратегии на заре постантибиотической эры. Колд Спринг Харб. Перспектива. Med. 3 , а010306 (2013). В этом обзоре подробно рассказывается о важности образования биопленок для выживания и устойчивости различных патогенов, а также об угрозе, которую представляют в клинических условиях.Кроме того, в нем обсуждаются новые альтернативные стратегии предотвращения образования биопленок.
PubMed PubMed Central Google Scholar
Розен Д. А., Хутон Т. М., Стамм В. Э., Хамфри П. А. и Халтгрен С. Дж. Обнаружение внутриклеточных бактериальных сообществ при инфекции мочевыводящих путей человека. PLoS Med. 4 , e329 (2007).
PubMed PubMed Central Google Scholar
Робино, Л.и другие. Внутриклеточные бактерии в патогенезе инфекции мочевыводящих путей Escherichia coli у детей. Clin. Заразить. Дис. 59 , e158 – e164 (2014).
CAS PubMed PubMed Central Google Scholar
Шварц, Д. Дж., Чен, С. Л., Халтгрен, С. Дж. И Сид, П. С. Популяционная динамика и нишевое распределение уропатогенных Escherichia coli во время острой и хронической инфекции мочевыводящих путей. Заражение. Иммун. 79 , 4250–4259 (2011).
CAS PubMed PubMed Central Google Scholar
Blango, M. G., Ott, E. M., Erman, A., Veranic, P. & Mulvey, M. A. Принудительное возрождение и нацеливание на внутриклеточные уропатогенные резервуары Escherichia coli . PLoS ONE 9 , e93327 (2014).
PubMed PubMed Central Google Scholar
Райс, Дж.C. et al. Пиелонефрит Escherichia coli , экспрессирующий P fimbriae, снижает иммунный ответ почек мыши. J. Am. Soc. Нефрол. 16 , 3583–3591 (2005).
CAS PubMed Google Scholar
Ашкар, А. А., Моссман, К. Л., Кумбс, Б. К., Гайлз, С. Л. и Маккензи, Р. Адгезин FimH фимбрий 1 типа является мощным индуктором врожденных антимикробных реакций, для которых требуется передача сигналов интерферона TLR4 и 1 типа. PLoS Pathog. 4 , e1000233 (2008).
PubMed PubMed Central Google Scholar
Герлах, Г. Ф., Клегг, С. и Аллен, Б. Л. Идентификация и характеристика генов, кодирующих фимбриальные адгезины типа 3 и типа 1 Klebsiella pneumoniae . J. Bacteriol. 171 , 1262–1270 (1989).
CAS PubMed PubMed Central Google Scholar
Stahlhut, S.G. et al. Сравнительный структурно-функциональный анализ маннозо-специфических адгезинов FimH из Klebsiella pneumoniae и Escherichia coli . J. Bacteriol. 191 , 6592–6601 (2009).
CAS PubMed PubMed Central Google Scholar
Rosen, D.A. et al. Молекулярные вариации в Klebsiella pneumoniae и Escherichia coli FimH влияют на функцию и патогенез мочевыводящих путей. Заражение. Иммун. 76 , 3346–3356 (2008).
CAS PubMed PubMed Central Google Scholar
Rosen, D. A. et al. Использование внутриклеточного бактериального сообщества при инфекции мочевыводящих путей Klebsiella pneumoniae и влияние FimK на экспрессию ворсинок 1 типа. Заражение. Иммун. 76 , 3337–3345 (2008).
CAS PubMed PubMed Central Google Scholar
Мерфи, К.Н., Мортенсен, М. С., Крогфельт, К. А. и Клегг, С. Роль фимбрий Klebsiella pneumoniae типа 1 и 3 в колонизации силиконовых трубок, имплантированных в мочевые пузыри мышей, в качестве модели катетер-ассоциированных инфекций мочевыводящих путей. Заражение. Иммун. 81 , 3009–3017 (2013).
CAS PubMed PubMed Central Google Scholar
Струве К., Бойер М. и Крогфельт К. А. Характеристика Klebsiella pneumoniae типа 1 фимбрий путем выявления фазовых изменений во время колонизации и инфекции и влияния на вирулентность. Заражение. Иммун. 76 , 4055–4065 (2008).
CAS PubMed PubMed Central Google Scholar
Армбрустер, К. Э. и Мобли, Х. Л. Слияние мифологии и морфологии: многогранный образ жизни Proteus mirabilis . Nature Rev. Microbiol. 10 , 743–754 (2012).
CAS Google Scholar
Ариас, К.A. & Murray, B.E. Рост числа Enterococcus : за пределами устойчивости к ванкомицину. Nature Rev. Microbiol. 10 , 266–278 (2012). Это всесторонний обзор эпидемиологии, патогенеза и механизма устойчивости к противомикробным препаратам Enterococcus spp. В этом обзоре также показано, как Enterococcus spp. становятся серьезной внутрибольничной проблемой.
CAS Google Scholar
Гитон, П.С., Хунг, С. С., Хэнкок, Л. Е., Капарон, М. Г. и Халтгрен, С. Дж. Образование и вирулентность энтерококковой биопленки в оптимизированной мышиной модели инфекций мочевыводящих путей, связанных с инородным телом. Заражение. Иммун. 78 , 4166–4175 (2010).
CAS PubMed PubMed Central Google Scholar
Nielsen, H. V. et al. Мотив сайта адгезии, зависящий от ионов металлов, пилина Enterococcus faecalis EbpA опосредует функцию пилуса при катетер-ассоциированной инфекции мочевыводящих путей. мБио 3 , e00177-12 (2012).
PubMed PubMed Central Google Scholar
Гобл, Н. М., Кларк, Т. и Хэммондс, Дж. С. Гистологические изменения мочевого пузыря, вторичные по отношению к катетеризации уретры. руб. J. Urol. 63 , 354–357 (1989).
CAS PubMed Google Scholar
Глан, Б. Э.Влияние условий дренажа на повреждение слизистой оболочки мочевого пузыря постоянными катетерами. I. Исследование давления. Сканд. J. Urol. Нефрол. 22 , 87–92 (1988).
CAS PubMed Google Scholar
Guiton, P. S., Hannan, T. J., Ford, B., Caparon, M. G. & Hultgren, S. J. Enterococcus faecalis преодолевает воспаление, опосредованное инородными телами, для установления инфекций мочевыводящих путей. Заражение.Иммун. 81 , 329–339 (2013).
CAS PubMed PubMed Central Google Scholar
Флорес-Мирелес, А. Л., Пинкнер, Дж. С., Капарон, М. Г. и Халтгрен, С. Дж. Вакцинные антитела против EbpA блокируют связывание Enterococcus faecalis с фибриногеном для предотвращения катетер-ассоциированной инфекции мочевого пузыря у мышей. Sci. Пер. Med. 6 , 254ra127 (2014). Это первое исследование, посвященное анализу механизма E.faecalis инфекция во время ОСТОРОЖНО; Эта работа привела к разработке вакцины, предотвращающей инфицирование модели CAUTI на мышах.
PubMed PubMed Central Google Scholar
Nielsen, H. V. et al. Остатки пилина и сортазы, критические для биогенеза пилингов, связанных с эндокардитом и биопленками, у Enterococcus faecalis . J. Bacteriol. 195 , 4484–4495 (2013).
CAS PubMed PubMed Central Google Scholar
Дхакал, Б. К. и Малви, М. А. Порообразующий токсин UPEC α-гемолизин запускает протеолиз белков-хозяев, нарушая клеточную адгезию, воспалительные процессы и пути выживания. Клеточный микроб-хозяин 11 , 58–69 (2012).
CAS PubMed PubMed Central Google Scholar
Нагамацу, К.и другие. Нарушение регуляции экспрессии α-гемолизина Escherichia coli изменяет течение острой и стойкой инфекции мочевыводящих путей. Proc. Natl Acad. Sci. США 112 , E871 – E880 (2015).
CAS PubMed Google Scholar
Mulvey, M.A. et al. Индукция и уклонение от защиты хозяина уропатогенными бактериями типа 1 Escherichia coli . Наука 282 , 1494–1497 (1998).
CAS PubMed Google Scholar
Justice, S. & Hunstad, D. A. Гемолизин UPEC: больше, чем просто для проделывания отверстий. Клеточный микроб-хозяин 11 , 4–5 (2012).
CAS PubMed PubMed Central Google Scholar
Hannan, T. J. et al. LeuX тРНК-зависимые и -независимые механизмы патогенеза Escherichia coli при остром цистите. Мол. Microbiol. 67 , 116–128 (2008).
CAS PubMed Google Scholar
Гарсия, Т. А., Вентура, С. Л., Смит, М. А., Меррелл, Д. С. и О’Брайен, А. Д. Цитотоксический некротический фактор 1 и гемолизин из уропатогенного Escherichia coli вызывают различные реакции хозяина в мочевом пузыре мыши. Заражение. Иммун. 81 , 99–109 (2013).
CAS PubMed PubMed Central Google Scholar
Ландро, Л.и другие. E. coli Токсин CNF1: система «два в одном» для инвазии клеток-хозяев. Внутр. J. Med. Microbiol. 293 , 513–518 (2004).
CAS PubMed Google Scholar
Piteau, M. et al. Гликопротеин адгезии Lu / BCAM является рецептором цитотоксического некротизирующего фактора 1 (CNF1) Escherichia coli . PLoS Pathog. 10 , e1003884 (2014).
PubMed PubMed Central Google Scholar
Дой, А.и другие. CNF1 использует механизм убиквитин-протеасомы для ограничения активации Rho GTPase для инвазии бактериальных клеток-хозяев. Cell 111 , 553–564 (2002).
CAS PubMed Google Scholar
Miraglia, A. G. et al. Цитотоксический некротический фактор 1 предотвращает апоптоз через путь киназы Akt / IκB: роль ядерного фактора-κB и Bcl-2. Мол. Биол. Ячейка 18 , 2735–2744 (2007).
CAS PubMed PubMed Central Google Scholar
Cestari, S.E. et al. Молекулярное определение гемолизина HpmA и HlyA уропатогенного белка Proteus mirabilis . Curr. Microbiol. 67 , 703–707 (2013).
CAS PubMed Google Scholar
Аламури П. и Мобли Х. Л. Новый аутотранспортер уропатогенного вируса Proteus mirabilis является одновременно цитотоксином и агглютинином. Мол. Microbiol. 68 , 997–1017 (2008).
CAS PubMed Google Scholar
Миттал, Р., Хандваха, Р. К., Гупта, В., Миттал, П. К. и Харджай, К. Фенотипические признаки мочевых изолятов Pseudomonas aeruginosa и их связь с почечной колонизацией мышей. Indian J. Med. Res. 123 , 67–72 (2006).
PubMed Google Scholar
Миттал, Р., Sharma, S., Chhibber, S. & Harjai, K. Железо определяет вирулентность Pseudomonas aeruginosa при инфекциях мочевыводящих путей. J. Biomed. Sci. 15 , 731–741 (2008).
PubMed Google Scholar
Rocha, C. L., Coburn, J., Rucks, E. A. и Olson, J. C. Характеристика экзофермента S Pseudomonas aeruginosa как бифункционального фермента в макрофагах J774A.1. Заражение.Иммун. 71 , 5296–5305 (2003).
CAS PubMed PubMed Central Google Scholar
Кэткарт, Г. Р. и др. Новые ингибиторы фактора вирулентности Pseudomonas aeruginosa LasB: потенциальный терапевтический подход для ослабления механизмов вирулентности при псевдомонадной инфекции. Антимикробный. Агенты Chemother. 55 , 2670–2678 (2011).
CAS PubMed PubMed Central Google Scholar
Мейерс, Д.J. et al. In vivo и in vitro Токсичность фосфолипазы C из Pseudomonas aeruginosa . Toxicon 30 , 161–169 (1992).
CAS PubMed Google Scholar
Wargo, M. J. et al. Ингибирование гемолитической фосфолипазы С защищает функцию легких во время инфекции Pseudomonas aeruginosa . Am. J. Respir. Крит. Care Med. 184 , 345–354 (2011).
CAS PubMed PubMed Central Google Scholar
Берка, Р. М. и Васил, М. Л. Фосфолипаза С (термолабильный гемолизин) из Pseudomonas aeruginosa : очистка и предварительная характеристика. J. Bacteriol. 152 , 239–245 (1982).
CAS PubMed PubMed Central Google Scholar
Сентурк, С., Ulusoy, S., Bosgelmez-Tinaz, G. & Yagci, A. Определение кворума и вирулентность Pseudomonas aeruginosa во время инфекций мочевыводящих путей. J. Infect. Dev. Страны 6 , 501–507 (2012).
CAS PubMed Google Scholar
Миттал, Р., Аггарвал, С., Шарма, С., Чхиббер, С. и Харджай, К. Инфекции мочевыводящих путей, вызванные Pseudomonas aeruginosa : мини-обзор. Дж.Заразить. Publ. Здравоохранение 2 , 101–111 (2009).
Google Scholar
Li, X. et al. Визуализация протеина Proteus mirabilis в матриксе камней мочевого пузыря, индуцированных уреазой, во время экспериментальной инфекции мочевыводящих путей. Заражение. Иммун. 70 , 389–394 (2002).
CAS PubMed PubMed Central Google Scholar
Гатерманн, С., Джон, Дж. И Марре, Р. Staphylococcus saprophyticus уреаза: характеристика и вклад в уропатогенность при беспрепятственной инфекции мочевыводящих путей у крыс. Заражение. Иммун. 57 , 110–116 (1989).
CAS PubMed PubMed Central Google Scholar
Podschun, R. & Ullmann, U. Klebsiella spp. как внутрибольничные возбудители: эпидемиология, систематика, методы типирования, факторы патогенности. Clin. Microbiol. Ред. 11 , 589–603 (1998).
CAS PubMed PubMed Central Google Scholar
Visca, P. et al. Детерминанты вирулентности у штаммов Pseudomonas aeruginosa от инфекций мочевыводящих путей. Epidemiol. Заразить. 108 , 323–336 (1992).
CAS PubMed PubMed Central Google Scholar
Гриффит Д.П., Мушер, Д. М., Итин, К. Уреаз. Основная причина инфекционных мочевых камней. Инвест. Урол. 13 , 346–350 (1976).
CAS PubMed Google Scholar
Кокер, К., Пур, К. А., Ли, X. и Мобли, Х. Л. Патогенез инфекции мочевыводящих путей Proteus mirabilis . Microbes Infect. 2 , 1497–1505 (2000).
CAS PubMed Google Scholar
Kosikowska, P.И Берлики, Л. Ингибиторы уреазы как потенциальные лекарства от инфекций желудка и мочевыводящих путей: обзор патентов. Мнение эксперта. Ther. Пат. 21 , 945–957 (2011).
CAS PubMed Google Scholar
Джонс, Б. Д. и Мобли, Х. Л. Генетическое и биохимическое разнообразие уреаз видов Proteus , Providencia и Morganella , выделенных при инфекции мочевыводящих путей. Заражение. Иммун. 55 , 2198–2203 (1987).
CAS PubMed PubMed Central Google Scholar
Стиклер Д. Дж. Клинические осложнения мочевых катетеров, вызванные кристаллическими биопленками: что-то нужно делать. J. Intern. Med. 276 , 120–129 (2014).
CAS PubMed Google Scholar
Каза, М.И Кронстад, Дж. У. Общие и различные механизмы приобретения железа бактериальными и грибковыми патогенами человека. Фронт. Клетка. Заразить. Microbiol. 3 , 80 (2013).
PubMed PubMed Central Google Scholar
Гарсия, Э. К., Брамбо, А. Р. и Мобли, Х. Л. Избыточность и специфичность систем получения железа Escherichia coli во время инфекции мочевыводящих путей. Заражение.Иммун. 79 , 1225–1235 (2011).
CAS PubMed PubMed Central Google Scholar
Watts, R.E. et al. Вклад систем сидерофоров в рост и колонизацию мочевыводящих путей бессимптомной бактериурией Escherichia coli . Заражение. Иммун. 80 , 333–344 (2012).
CAS PubMed PubMed Central Google Scholar
Вальдебенито, М., Crumbliss, A. L., Winkelmann, G. & Hantke, K. Факторы окружающей среды влияют на выработку энтеробактина, сальмохелина, аэробактина и иерсиниабактина в штамме Escherichia coli Nissle 1917. Int. J. Med. Microbiol. 296 , 513–520 (2006).
CAS PubMed Google Scholar
Чатурведи, К. С., Хунг, С. С., Кроули, Дж. Р., Стэплтон, А. Э. и Хендерсон, Дж. П. Сидерофор иерсиниабактин связывает медь для защиты патогенов во время инфекции. Nature Chem. Биол. 8 , 731–736 (2012).
CAS Google Scholar
Himpsl, S. D. et al. Протеобактин и родственный иерсиниабактину сидерофор опосредуют приобретение железа у Proteus mirabilis . Мол. Microbiol. 78 , 138–157 (2010).
CAS PubMed PubMed Central Google Scholar
Брамбо, А.Р., Смит, С. Н. и Мобли, Х. Л. Иммунизация рецептором иерсиниабактина, FyuA, защищает от пиелонефрита на мышиной модели инфекции мочевыводящих путей. Заражение. Иммун. 81 , 3309–3316 (2013). В этом исследовании используются данные геномного, протеомного и метаболического скринингов для идентификации мишеней вакцины в E. coli ., Все из которых участвуют в получении железа. Вакцинация несколькими рецепторами железа во время экспериментальных ИМП у мышей показала, что эти факторы были эффективной мишенью для разработки вакцин.
CAS PubMed PubMed Central Google Scholar
Патерсон, Д. Л. Устойчивость грамотрицательных бактерий: Enterobacteriaceae. Am. J. Infect. Контроль 34 , S20 – S28 (2006).
PubMed Google Scholar
Гарау Дж. Другие противомикробные препараты, представляющие интерес в эпоху β-лактамаз расширенного спектра действия: фосфомицин, нитрофурантоин и тигециклин. Clin. Microbiol. Заразить. 14 , 198–202 (2008).
CAS PubMed Google Scholar
Пендлтон, Дж. Н., Горман, С. П. и Гилмор, Б. Ф. Клиническая значимость патогенов ESKAPE. Expert Rev. Anti Infect. Ther. 11 , 297–308 (2013).
CAS PubMed Google Scholar
Гупта К. и Бхаделиа Н.Лечение инфекций мочевыводящих путей, вызванных микроорганизмами с множественной лекарственной устойчивостью. Заражение. Дис. Clin. North Am. 28 , 49–59 (2014).
PubMed Google Scholar
Брэдфорд, П. А. β-лактамазы расширенного спектра в 21 веке: характеристика, эпидемиология и обнаружение этой важной угрозы устойчивости. Clin. Microbiol. Ред. 14 , 933–951 (2001).
CAS PubMed PubMed Central Google Scholar
Курвалин, П.Устойчивость грамположительных кокков к ванкомицину. Clin. Заразить. Дис. 42 (Приложение 1), S25 – S34 (2006).
CAS PubMed Google Scholar
Жанель Г.Г. и др. Цефтазидим – авибактам: новая комбинация ингибиторов цефалоспоринов и β-лактамаз. Наркотики 73 , 159–177 (2013).
CAS PubMed Google Scholar
Ливермор, Д.M. & Mushtaq, S. Активность биапенема (RPX2003) в сочетании с ингибитором боронат-β-лактамазы RPX7009 против устойчивых к карбапенему Enterobacteriaceae. J. Antimicrob. Chemother. 68 , 1825–1831 (2013).
CAS PubMed Google Scholar
Mushtaq, S., Woodford, N., Hope, R., Adkin, R. & Livermore, DM Активность BAL30072 отдельно или в сочетании с ингибиторами β-лактамазы или с меропенемом в отношении устойчивых к карбапенему Enterobacteriaceae и не- ферментеры. J. Antimicrob. Chemother. 68 , 1601–1608 (2013).
CAS PubMed Google Scholar
Асади Карам, М. Р., Олуми, М., Махдави, М., Хабиби, М. и Бузари, С. Вакцинация рекомбинантным FimH, слитым с флагеллином, усиливает клеточный и гуморальный иммунитет против инфекции мочевыводящих путей у мышей. Вакцина 31 , 1210–1216 (2013).
CAS PubMed Google Scholar
Лангерманн, С.и другие. Вакцинация адгезином FimH защищает яванских макак от колонизации и инфицирования уропатогенными бактериями Escherichia coli . J. Infect. Дис. 181 , 774–778 (2000).
CAS PubMed Google Scholar
Langermann, S. et al. Профилактика инфекции слизистой оболочки Escherichia coli с помощью системной вакцинации на основе FimH-адгезина. Наука 276 , 607–611 (1997). Это ключевое исследование показывает, что блокирование взаимодействия между бактериальным адгезином и рецептором хозяина посредством вакцинации может предотвратить ИМП у мышей.
CAS PubMed Google Scholar
Робертс, Дж. А. и др. Ответы антител и защита от пиелонефрита после вакцинации очищенным белком Escherichia coli PapDG. J. Urol. 171 , 1682–1685 (2004).
CAS PubMed PubMed Central Google Scholar
Savar, N. S. et al. In silico и in vivo исследования усеченных форм флагеллина (FliC) энтероагреганта Escherichia coli , слитого с FimH из уропатогенного Escherichia coli в качестве кандидата на вакцину против инфекций мочевыводящих путей. J. Biotechnol. 175 , 31–37 (2014).
CAS PubMed Google Scholar
Li, X.и другие. Использование трансляционного слияния фимбриального адгезин-связывающего домена MrpH с доменом холерного токсина A2, коэкспрессируемым с субъединицей холерного токсина B, в качестве интраназальной вакцины для предотвращения экспериментальной инфекции мочевыводящих путей с помощью Proteus mirabilis . Заражение. Иммун. 72 , 7306–7310 (2004).
CAS PubMed PubMed Central Google Scholar
Сивик, К. Э. и Мобли, Х.L. Ведение войны с уропатогенными бактериями Escherichia coli : возвращение мочевыводящих путей. Заражение. Иммун. 78 , 568–585 (2010).
CAS PubMed Google Scholar
O’Hanley, P., Lalonde, G. & Ji, G. Альфа-гемолизин способствует патогенности пилированного дигалактозид-связывающего Escherichia coli в почках: эффективность вакцины α-гемолизина в предотвращении Повреждение почек на мышиной модели пиелонефрита BALB / c. Заражение. Иммун. 59 , 1153–1161 (1991).
CAS PubMed PubMed Central Google Scholar
Alamuri, P., Eaton, KA, Himpsl, SD, Smith, SN & Mobley, HL Вакцинация протеус-токсичным агглютинином, гемолизин-независимым цитотоксином in vivo , защищает от инфекции мочевыводящих путей Proteus mirabilis . Заражение. Иммун. 77 , 632–641 (2009).
CAS PubMed Google Scholar
Алтери, К. Дж., Хаган, Е. С., Сивик, К. Е., Смит, С. Н. и Мобли, Х. Л. Иммунизация слизистой оболочки антигенами рецептора железа защищает от инфекции мочевыводящих путей. PLoS Pathog. 5 , e1000586 (2009).
PubMed PubMed Central Google Scholar
Нагая, Х., Сато, Х., Кубо, К.& Маки, Ю. Возможный механизм ингибирования желудочной (H + + K + ) -аденозинтрифосфатазы ингибитором протонной помпы AG-1749. J. Pharmacol. Exp. Ther. 248 , 799–805 (1989).
CAS PubMed Google Scholar
Sjostrom, J. E., Kuhler, T. & Larsson, H. Основа для селективной антибактериальной активности in vitro ингибиторов протонной помпы против Helicobacter spp. Антимикробный. Агенты Chemother. 41 , 1797–1801 (1997).
CAS PubMed PubMed Central Google Scholar
Pinkner, J. S. et al. Рационально разработанные небольшие соединения ингибируют биогенез пилуса уропатогенных бактерий. Proc. Natl Acad. Sci. США 103 , 17897–17902 (2006).
CAS PubMed Google Scholar
Кусумано, К.K. et al. Лечение и профилактика инфекций мочевыводящих путей с помощью пероральных ингибиторов FimH. Sci. Пер. Med. 3 , 109ра115 (2011). В этой ключевой работе используются соединения, разработанные для предотвращения связывания адгезина пилуса E. coli типа 1 с рецептором хозяина, и демонстрируется, что эти соединения эффективны для предотвращения ИМП у мышей.
PubMed PubMed Central Google Scholar
Грин, С.E. et al. Пилицид ec240 нарушает цепи вирулентности в уропатогенной кишечной палочке E. coli . мБио 5 , e02038 (2014). Это первая статья, описывающая роль пилицида в регуляции транскрипции и трансляции в UPEC.
CAS PubMed PubMed Central Google Scholar
Abgottspon, D. et al. Разработка анализа агрегации для скрининга антагонистов FimH. Дж.Microbiol. Методы 82 , 249–255 (2010).
CAS PubMed Google Scholar
Klein, T. et al. Антагонисты FimH для перорального лечения инфекций мочевыводящих путей: от разработки и синтеза до in vitro и in vivo оценки . J. Med. Chem. 53 , 8627–8641 (2010).
CAS PubMed Google Scholar
Тоцика, М.и другие. Ингибитор FimH предотвращает острую инфекцию мочевого пузыря и лечит хронический цистит, вызванный уропатогенными бактериями с множественной лекарственной устойчивостью Escherichia coli ST131. J. Infect. Дис. 208 , 921–928 (2013).
CAS PubMed PubMed Central Google Scholar
Schwartz, D. J. et al. Положительно выбранные остатки FimH усиливают вирулентность при инфекции мочевыводящих путей за счет изменения конформации FimH. Proc. Natl Acad. Sci. США 110 , 15530–15537 (2013). Это исследование определяет роль ключевых остатков FimH в конформации и вирулентности белка.
CAS PubMed Google Scholar
Сокуренко, Е. В., Чеснокова, В., Дойл, Р. Дж. И Хасти, Д. Л. Разнообразие фимбриального лектина Escherichia coli типа 1. Дифференциальное связывание с маннозидами и уроэпителиальными клетками. Дж.Биол. Chem. 272 , 17880–17886 (1997).
CAS PubMed Google Scholar
Weissman, S.J. et al. Дифференциальная стабильность и компромиссные эффекты патоадаптивных мутаций в адгезине Escherichia coli FimH. Заражение. Иммун. 75 , 3548–3555 (2007).
CAS PubMed PubMed Central Google Scholar
Джастис, С.С., Хунстад, Д. А., Цегельски, Л., Халтгрен, С. Дж. Морфологическая пластичность как стратегия выживания бактерий. Nature Rev. Microbiol. 6 , 162–168 (2008).
CAS Google Scholar
Horvath, D. J. Jr et al. Морфологическая пластичность способствует устойчивости к уничтожению фагоцитами уропатогенной Escherichia coli . Microbes Infect. 13 , 426–437 (2011).
CAS PubMed Google Scholar
Данезе, П.Н., Пратт, Л. А., Дав, С. Л. и Колтер, Р. Белок внешней мембраны, антиген 43, опосредует межклеточные взаимодействия в биопленках Escherichia coli . Мол. Microbiol. 37 , 424–432 (2000).
CAS PubMed Google Scholar
Lane, M.C., Li, X., Pearson, M.M., Simms, A.N. & Mobley, H.L. Условия ограничения кислорода обогащают фимбриатные клетки уропатогенных Proteus mirabilis и Escherichia coli . J. Bacteriol. 191 , 1382–1392 (2009).
CAS PubMed Google Scholar
Yu, H. et al. Эластаза LasB из Pseudomonas aeruginosa способствует образованию биопленок частично за счет регуляции, опосредованной рамнолипидом. Кан. J. Microbiol. 60 , 227–235 (2014).
CAS PubMed Google Scholar
Диггл, С.P. et al. Галактофильный лектин, LecA, способствует развитию биопленок у Pseudomonas aeruginosa . Environ. Microbiol. 8 , 1095–1104 (2006).
CAS PubMed Google Scholar
Fazli, M. et al. Регуляция образования биопленок у видов Pseudomonas и Burkholderia . Environ. Microbiol. 16 , 1961–1981 (2014).
CAS PubMed Google Scholar
Вагнер, В.Э., Ли, Л. Л., Изабелла, В. М. и Иглевски, Б. Х. Анализ иерархии регуляции кворума у Pseudomonas aeruginosa . Анал. Биоанал. Chem. 387 , 469–479 (2007).
CAS PubMed Google Scholar
Кумар Р., Чиббер С. и Харджай К. Зондирование кворума необходимо для определения вирулентности Pseudomonas aeruginosa во время инфекции мочевыводящих путей. Kidney Int. 76 , 286–292 (2009).
CAS PubMed Google Scholar
Джастис, С. С., Хунстад, Д. А., Сид, П. К. и Халтгрен, С. Дж. Филаментация кишечной палочки Escherichia coli подрывает врожденную защиту во время инфекции мочевыводящих путей. Proc. Natl Acad. Sci. США 103 , 19884–19889 (2006).
CAS PubMed Google Scholar
Моргенштейн, Р.M. & Rather, P. N. Роль белков Umo и фосфора Rcs в роящей подвижности дикого типа и мутанта O-антигена ( waaL ) из Proteus mirabilis . J. Bacteriol. 194 , 669–676 (2012).
CAS PubMed PubMed Central Google Scholar
Вальтер-Расмуссен, Дж. И Хойби, Н. Цефотаксимазы (CTX-M-азы), расширяющееся семейство β-лактамаз расширенного спектра действия. Кан. J. Microbiol. 50 , 137–165 (2004).
CAS PubMed Google Scholar
Schwan, W. R. Flagella позволяют уропатогенным Escherichia coli проникать в почки мышей. Внутр. J. Med. Microbiol. 298 , 441–447 (2008).
CAS PubMed Google Scholar
Ulett, G.C. et al.Функциональный анализ антигена 43 в уропатогенном кишечнике Escherichia coli показывает его роль в длительном сохранении в мочевыводящих путях. Заражение. Иммун. 75 , 3233–3244 (2007).
CAS PubMed PubMed Central Google Scholar
Таркканен, А. М. и др. Системы фимбриации, капсулирования и удаления железа у штаммов Klebsiella , связанных с инфекцией мочевыводящих путей человека. Заражение. Иммун. 60 , 1187–1192 (1992).
CAS PubMed PubMed Central Google Scholar
Подшун, Р., Сиверс, Д., Фишер, А. и Ульманн, У. Серотипы, гемагглютинины, синтез сидерофоров и сывороточная резистентность изолятов Klebsiella , вызывающих инфекции мочевыводящих путей человека. J. Infect. Дис. 168 , 1415–1421 (1993).
CAS PubMed Google Scholar
Думански, А.Дж., Хеделин, Х., Эдин-Лильегрен, А., Бошемин, Д. и Маклин, Р. Дж. Уникальная способность капсулы Proteus mirabilis увеличивать рост минералов в инфекционных мочевых камнях. Заражение. Иммун. 62 , 2998–3003 (1994).
CAS PubMed PubMed Central Google Scholar
Коул, С. Дж., Рекордс, А. Р., Орр, М. В., Линден, С. Б. и Ли, В. Т. Катетер-ассоциированная инфекция мочевых путей, вызванная Pseudomonas aeruginosa , опосредуется экзополисахарид-независимыми биопленками. Заражение. Иммун. 82 , 2048–2058 (2014).
PubMed PubMed Central Google Scholar
Гупта П., Гупта Р. К. и Харджай К. Множественные факторы вирулентности, регулируемые кворумом, могут помочь в установлении и заселении мочевыводящих путей Pseudomonas aeruginosa во время экспериментальной инфекции мочевыводящих путей. Indian J.